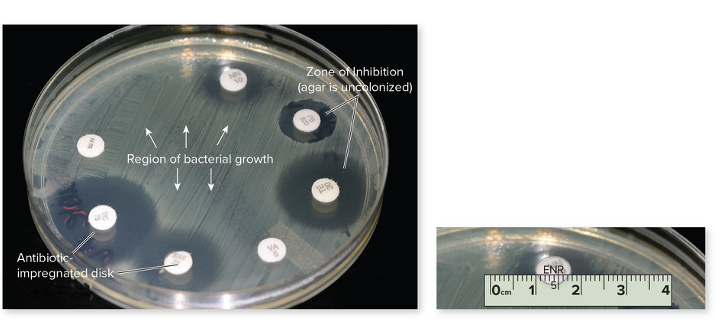
card image
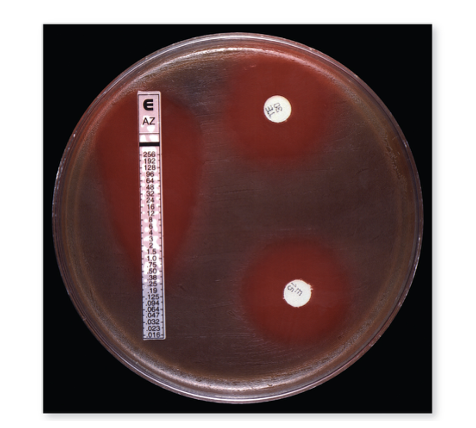
card image

CHAPTER 18
Diagnosing Infections
What are the three categories of methods to identify unknown bacteria?
Phenotypic, Immunological, and Genotypic
What is phenotypic testing?
Observation of microbe’s microscopic and macroscopic morphology, physiology, antimicrobial susceptibility, and biochemical properties

What is immunological testing?
Analysis of microbe using antibodies or of patients’ antibodies using prepackaged antigens

Genotypic
Analysis of microbe’s DNA or RNA
What are the different sample sites for collection?
Saliva, Sputum (thick stuff from a hacking cough), swab
- Blood
- Urine (through catheter or clean catch)
- Skin (swab)
- Spinal tap (CSF)
- Feces
- Vaginal swab or stick or Penis swab/stick
- Skin (scalpel)
What is a culturette?

A sterile transport swab with a carrier
What happens once you collect a specimen?
It's promptly transported to a LAB, stored appropriately (usually in the fridge)
- Special swab and transport systems can be used to maintain it in a stable condition for hour
- May have nonnutritive maintenance media, buffering system, or anaerobic environment to prevent the destruction of O2 sensitive bacteria.
Phenotypical method relates to ____________.
Expression of genes that is UNIQUE to that particular microbe
Phenotypic testing is based on the expression of a microbe’s genes, which lets us observe what the organism is actually doing — such as how it stains, how it grows or reacts on different media, and what its cell shape and structure (morphology) look like.
How is a specimen cultivated, and what are the two different medias that can be used?
After a specimen (like blood, urine, or a throat swab) is collected, cultivation means growing and multiplying any microorganisms that might be present in that sample under controlled lab conditions.
This can mean using specialized media that reveals identifying characteristics such as colony appearance, motility, and gas requirements.
- Selective media: encourage growth of only one pathogen and used to enrich specimen.
- Differential: identify definitive characteristics and fermentation patters (bacteria itself is NOT changing, but the plate is changing)
In phenotypic testing, we’re not changing the bacteria itself (its genetics or inherent traits) — instead, we’re changing the environment, like the type of plate or media the bacteria is grown on.
For example:
- You might grow the same bacterial species on blood agar to see if it causes hemolysis, or on MacConkey agar to see if it ferments lactose.
- The bacteria stays the same, but its observable characteristics (phenotype) may look different because the plate conditions highlight different traits.
What are hemolysins?
Enzymes that lyse RBCs to release iron-rich hemoglobin so bacteria is able to multiply. Beta, Alpha, and Gamma. Some microbes like to extract nutrients from RBCs.
What is a dichotomous key?

Graphic method that essentially a flowchart leading to the identification of specimens. It allows you graph all the way down to a particular microbe.
What is biochemical testing?

Physiological reactions (physical change like color, bubbling, shape) of bacteria to nutrients and a special substrates provide indirect evidence of enzyme systems. This can be done manually or by machines.
- These tests are based on enzyme-mediated metabolic reactions, and usually visualized by a color change.
If you have a unknown microbe and a substrate, if there's product, the enzyme is there (and that microbe)
No product, then the enzyme is not there, and it lacks the enzyme that can utilize that substrate.
Explain the connection in biochemical testing between substrate, enzyme, and final product.
Biochemical testing is all about seeing what enzymes the bacteria have and how those enzymes react with specific substrates.
Think of it like giving the bacteria a little “quiz”:
- Each test gives it a different substrate (like sugar, amino acid, or chemical).
- If the bacteria has the right enzyme, it’ll “use” or break down that substrate — and you’ll see a reaction (color change, gas, acid, etc.).
- If it doesn’t have that enzyme, nothing happens.
All those reactions together form a kind of metabolic profile, which scientists use to identify the microbe.
What is antimicrobial susceptibility testing?
This is used in determining drugs to be used in treatment. Most of the atuomated phenotypic systems incorporate a panel of commonly used antimicrobials for the particular infection site and stimultaneously test susceptibility while identifying the pathogen
- Patterns of sensitivity can be used in the presumptive identification of some species of Streptococcus, Clostridium, and Pseudomonas
- In the lab, if a bacterium stops growing when exposed to a certain antibiotic, it’s sensitive — meaning that antibiotic would likely work in a patient.
- If it keeps growing, it’s resistant, meaning that antibiotic wouldn’t help much.
And yes
What is phage testing?
Involves inoculating a lawn of cells onto agar in a Petri dish, mapping off blocks, and applying a different phage to each sectioned area of growth. Cleared areas corresponding to lysed cells indicate sensitivity to that phage.
- Involves viruses that attack bacteria in species-specific and strain specific ways.
- Used for tracing bacterial strains in epidemics.
Here’s how it works step-by-step:
- You grow a lawn of bacteria (a uniform layer of bacterial growth) on an agar plate. - can be through a liquid culture spread on the agar plate.
- The plate is divided into sections, and a different bacteriophage (virus) is added to each section. (doted onto the agar)
- Each bacteriophage is specific — it only infects certain bacterial species or even certain strains within a species.
- After incubation, you look for clear zones, called plaques, where the bacteria have been lysed (destroyed) by the phage.
What microbe is easy to identify with phage testing?
Salmonella
If bacteria has specific receptors that phage is looking for THEN it can get inside. In other words, very particular phages will recognize bacteria and get inside bacteria via recognition of expression of proteins or receptors. If bacteria does not correct proteins for virus to adsorb too, then it will NOT bind to and cause cell death
All about the expression of proteins that allow the virus to get in, and kill bacteria cell
How do you determine the clinical significance of cultures?
It is important to recognize if an isolated colony is clinically important (is there an infection?) or merely a contaminant or normal biota.
- Focus on the number of microbes (ex. few colonies of E. coli can be normal biota but a hundred colonies would mean an active infection). Sometimes, a single colony might mean an infection if it's not normal biota.
Ex. With mycobacterium tuberculosis, even finding just one colony of a known disease-causing organism (a true pathogen), or an opportunist in a place that should be completely sterile, is a strong indication that it’s causing an infection.
What are the drawbacks of phenotypic methods?
Culturing microbes takes a minimum of 18-24 hrs (often longer)
Many infectious conditions can be caused by non-culturable organisms, leaving a wide range of chance that the organism we do culture is a bystander.
What are the five different types of phenotypic testing? Which one DOES NOT require cultivation?
MS DSB - Master's in DSB
- Miscellaneous (Phage typing, cell culture growth, and animal inoculation)
- Cell culture growth = growing microbes inside living cells to detect or study infections that can’t be seen on regular agar media.
- Animal Inoculation = If a sputum sample is suspected to contain Mycobacterium tuberculosis, but it’s hard to grow on media, scientists might inoculate a guinea pig. If the animal develops tuberculosis-like symptoms, that confirms the presence of M. tuberculosis.
- Susceptibility testing: a particular pattern of antimicrobial susceptibilities can lead to the identity of a microbe
- Direct examination (NO CULTIVATION):
Microscopy of patient specimens, usually after staining
- Selective/differential growth: Use of specialized media that reveal identifying characteristics such as colony appearance, motility, and gas requirements
- Biochemical testing: Growth of microbe in media that detects the presence of microbe’s enzymes, creating a metabolic fingerprint
In immunological methods, what is serology?
Serology is the diagnostic testing of blood serum (the clear part of your blood) to detect antibodies or antigens related to infections
- Antibodies have extreme specificity for antigens
- Looking at the interaction between antibodies and antigens can help determine cause of disease.
- An unknown antibody can be detected using a known antigen or an unknown antigen can be detected using a known antibody.
With the same techniques used in serology, we can also detect immune markers in what other specimens?
Sera, Urine, CSF, whole tissues, saliva
What are the two basic sides towards serological testing?
First scenario: In patient's serum, the antibody is UNKNOWN. We added prepared microbial agent. If it binds, then it tells you that the person has the antibody (agglutination)
- tests if a person has antibodies (immunity/exposure).
Second scenario: You have an isolated colony of unknown microbes. But you have antibodies of a known identify. When you combine them, if they bind, you can tell (agglutinations), if they don't, you know it's not that microbe.
- identifies the specific bacterium or strain.
The presence of antibodies in someone's system can show what things?
They had the infection, or they have a vaccine against it
What are the 7 different types of immunological diagnostic methods?
PIA is a WIFE (acronym)
- Precipitation: Smaller complexes of antibody–antigen.
- Immunochromatography: Most common form is a lateral flow system, supplied in prepackaged cartridges that produce a colored stripe.
- Agglutination: Antibody-mediated clumping of whole cells.
- Western Blot: Electrophoresis separates proteins (either antigens or antibodies) and then labeled antibodies or antigens are used for detection.
- In vivo tests: Antigen introduced into a patient to elicit a reaction as in TB skin test.
- Fluorescent antibodies:
- Direct (DFA): Unknown specimen is exposed to known fluorescent Ab.
- Indirect (IFA): Patient’s antibody (its Fc portion) is probed with fluorescent Ab.
- ELISA: Sandwiching technique conducted in microwells using Ag, Ab, and a secondary Ab to produce a color change.
** note even if there's a color change, it is still this because it can happen due to binding between antibody and antigen.
True or False:
- The binding reaction of an antibody (Ab) to a specific site (epitope) on an antigen (Ag) is visible to the naked eye and in the light microscopy
FALSE
But,
- But if the antigens and antibody are suspended in a solution, under the right circumstances, the presence of binding can be seen as clumps in the solution
What are the three essential differences between agglutination and precipitation?

1. Size
2. Solubility
3. Location of antigen
What is the difference between agglutination and precipitation?
In both reactions, antigen is interlinked by several antibodies to form insoluble clumps that settle out of solution.
Mostly, it's the parts of the antigen vs. whole antigen.
In agglutination, antigens are whole cells such as RBCs, bacteria, or viruses displaying surface antigens. This is seen MORE easily because of visible clumps.
- Red blood cells have surface antigens that determine your blood type (A, B, AB, or O).
- Bacteria and viruses have unique surface antigens that your immune system uses to recognize and attack them.
Precipitation: antigen is a soluble molecule.
What common test is agglutination used for?
Determining blood compatibility.
What is immunochromatography?
- Lateral flow test
- pregnancy, COVID-19 tests
- This is a plastic cartilage that directs fluid flow in one direction, where it will encounter antibodies.
- When the antigen encounters the antibodies, there is a color change.
What are the steps to a lateral flow test?
- Sample applied: You put the fluid (blood, saliva, urine) onto the sample pad.
- Capillary action: The fluid naturally moves along the test strip by capillary action (like liquid wicking through paper).
- Conjugate pad release: As the sample passes the conjugate pad, it picks up the labeled antibodies stored there. These antibodies are usually attached to a visible marker (gold nanoparticles, colored beads, etc.).
- ________________________
- Migration to test line: The sample–antibody complex continues to move along the strip until it reaches the test line, where immobilized antibodies are waiting.
- These immobilized antibodies are also specific to the same antigen, but they bind to a different part (epitope) of the antigen than the conjugate antibody.
- When the antigen is sandwiched between the labeled antibody and the immobilized antibody, it forms a stable complex that stays at the test line.
- The visible marker on the conjugate antibody creates the line you can see, indicating a positive result.
- _________________________
- Binding and signal: If the target antigen is present, the labeled antibody–antigen complex binds to the immobilized antibodies at the test line, forming a visible line.
What is an antibody titer?
- The concentration of antibodies in a sample.
This tells us the minimum amount of antibody needed to react with the antigen.
- Antibody titer measures the concentration of antibodies in a patient’s serum by serially diluting it with a known antigen and identifying the highest dilution that still produces agglutination, helping diagnose past infections, immunity, or autoimmune disorders.
For bacteria, what is the difference between serotypes and serotyping?
- Serotypes = subgroups of a bacterial species that differ in their surface antigens (like capsule, flagella, or cell wall molecules).
- Serotyping = a lab method that uses antigen–antibody reactions to identify and classify bacteria based on these surface antigens.
- Labs use antisera (solutions containing antibodies) that specifically bind to certain bacterial antigens. If binding occurs, it confirms the serotype of the bacteria.
What is a western blot test?
- A sample of proteins from a bacterial cell or virus is separated via electrical charge within a gel
- The proteins distributed throughout the gel are transferred and immobilized on a filter
- The filter is incubated with patient fluid, such as serum, to see if antibodies are present that are compatible with the test antigen
- Sites of specific antigen–antibody binding will appear as a pattern of bands that can be compared with known positive and negative controls
- In a Western blot, the proteins separated from the pathogen (bacteria, virus, etc.) are the antigens.
- The patient’s antibodies in the serum are what recognize and bind to those antigens if the person has been exposed or infected.
- So when a band appears on the blot, it means the patient’s antibodies found a matching antigen.
What do you do know a western blot test?
In a Western blot, the lab knows the antigens — they are the proteins from the pathogen that are separated and immobilized on the membrane.
- What’s unknown is whether the patient has antibodies that recognize those antigens.
- By adding the patient’s serum, you can see which antibodies, if any, bind to the known antigens.
- The presence of binding (bands) tells you the patient has antibodies specific to that pathogen, indicating past or current exposure.
How many antibodies are used in western blot?

In this setup, there are usually two different antibodies involved, each with a specific role:
- Start with the antigen (protein):
- You have a specific protein from a microbe that you want to detect antibodies against.
- Add patient antibodies:
- You don’t know if the patient has antibodies to this protein yet.
- If the patient’s antibodies bind to the protein, it means they have been exposed to the microbe or have immunity.
- Add secondary antibody:
- A secondary antibody recognizes the patient’s antibody.
- This secondary antibody is labeled with a marker, often a fluorescent tag.
- Detection:
- When the secondary antibody binds, the fluorescent tag produces a visible signal or color change, showing where the binding occurred.
What are the two types of immunofluorescence testing?
1. Indirect Testing
- Start with the antigen:
- You have a known antigen (like a protein from a microbe) on a slide.
- Add patient serum:
- The patient’s serum may contain antibodies that recognize that antigen, but you don’t know yet.
- Add fluorescent secondary antibody:
- This antibody is labeled with a fluorescent tag and specifically binds to the Fc region of the patient’s antibodies.
- Fc region = the “tail” part of the antibody, not the part that binds the antigen.
- Detection:
- If the patient has antibodies against the antigen, the secondary antibody binds to them, forming antigen–antibody complexes.
- Under a fluorescence microscope, these complexes light up, showing a positive reaction.
Main idea:
Indirect IFA detects unknown antibodies in patient serum by using a fluorescent-labeled secondary antibody to visualize them bound to a known antigen.
2. Direct Testing
- What’s being tested:
- The unknown antigen (from a specimen) is fixed onto a slide. This could be a cell, tissue, or microbial sample.
- Adding
antibodies:
- You apply a fluorescently labeled antibody (FAb) that has a known specificity — it’s designed to bind to the antigen if it’s present.
- Detection:
- If the antigen is present, the labeled antibody will bind directly to it.
- You then use a fluorescence microscope to see the glowing signal where the antibody attached.
- “Direct” = the fluorescent label is on the primary antibody itself.
- Unknown antigen + known labeled antibody → binding → fluorescence signal.
- Used for quick identification of pathogens or proteins in tissue samples.
What is known and not known between indirect and direct testing?
Direct Immunofluorescence (DIF)
- Known: The antibody is known and already labeled with a fluorescent tag.
- Unknown: The antigen in the patient sample — you’re testing whether it’s present.
- Summary: Direct = known antibody looks for unknown antigen.
Indirect Immunofluorescence (IFA)
- Known: The antigen on the slide is known.
- Unknown: The patient’s antibodies — you’re testing whether the serum contains antibodies against the antigen.
- Summary: Indirect = known antigen looks for unknown antibody.
What's the difference between Indirect Testing and Western Blot?
- IFA = “glowing cells” → tells you antibodies exist.
- Western blot = “band barcode” → tells you which proteins the antibodies bind to.
What is ELISA?
Enzyme-Linked Immunosorbent Assay (ELISA)
- Uses an enzyme-linked indicator antibody to visualize antigen – antibody reactions. Lab test used to detect the presence of either antigens or antibodies in a sample using enzyme-linked antibodies that produce a color change.
What's the difference between Direct, Indirect and Sandwich ELISA?
1. Direct ELISA
- Known: The antibody on the plate is known and enzyme-linked.
- Unknown: The antigen in the sample.
- Summary: Direct ELISA = detecting unknown antigen using a known labeled antibody.
2. Indirect ELISA
- Known: The antigen on the plate is known.
- Unknown: The antibody in the patient’s sample.
- Summary: Indirect ELISA = detecting unknown antibody using a known antigen and secondary labeled antibody.
3. Sandwich ELISA
- Known: Two antibodies — one immobilized on the plate and one enzyme-linked secondary antibody.
- Unknown: The antigen in the sample.
- Summary: Sandwich ELISA = captures unknown antigen between two known antibodies for high specificity.
What is Indirect ELISA?

- Start with a known antigen:
- The antigen is stuck to the bottom of a well in a plate.
- Add
patient serum:
- If the patient has antibodies against that antigen, they will bind and stay in the well even after washing. The unbound antibodies will be washed out.
- Add enzyme-linked secondary antibody:
- This indicator antibody binds to the patient’s antibody (specifically the Fc region of the bound antibody)
- Add
substrate:
- The enzyme reacts with a colorless substrate to produce a color change.
- Interpretation:
- Color = patient has antibodies against that antigen → positive result.
- No color = no antibodies detected → negative result.
___________________________________
- In an ELISA, the secondary antibody has an enzyme attached.
- You add a colorless substrate to the well.
- If the enzyme is present (meaning the patient antibody bound to the antigen), it reacts with the substrate and breaks it down (hydrolyzes it).
- This reaction produces a colored product, so the well turns color.
- If there’s no antibody binding, the enzyme isn’t there, the substrate stays colorless, and the well stays clear, which is a negative result.
What is the sandwhich ELISA?

Two antibodies.
- Start with a known antibody:
- The antibody is stuck to the bottom of a well.
- Add the
sample with unknown antigen:
- If the antigen is present, it binds to the antibody, forming the first part of the “sandwich.”
- Add a secondary antibody:
- This is another antibody that binds to the antigen and usually has an enzyme attached.
- Add
substrate → color change:
- The enzyme reacts with the substrate to produce color, showing a positive result.
- No color means the antigen is absent → negative.
- Modern variation:
- Some tests use computer chips that detect tiny electrical changes instead of color to sense if the antigen–antibody complex forms.
What is the goal of each of the ELISAs
1. Direct ELISA
- Goal: Detect the presence of a specific antigen in a sample.
- Key: Uses a known enzyme-linked antibody to bind directly to the antigen.
2. Indirect ELISA
- Goal: Detect antibodies in a patient’s serum against a known antigen.
- Key: Uses a secondary enzyme-linked antibody to detect patient antibodies.
3. Sandwich ELISA
- Goal: Detect antigen with high specificity and sensitivity.
- Key: Antigen is “captured” between two antibodies (capture + detection).
What is the complement fixation test?

Many viral and fungal diseases are diagnosed using the principle that complement can lyse red blood cells
KNOWN: antigen
unknown: patient's antibodies
- Purpose: Detect antibodies in a patient’s serum against a known antigen.
- How it works:
- You mix the patient’s serum (unknown antibodies) with a known antigen and complement proteins.
- If antibodies are present, they bind the antigen and “fix” the complement — meaning the complement is used up in forming the antibody–antigen complex.
- If no antibodies are present, the complement stays free.
- Detection using red blood cells
(RBCs):
- Add indicator RBCs + anti-RBC antibodies.
- Positive result: No lysis of RBCs (complement was used up by patient antigen–antibody complexes).
- Negative result: RBCs are lysed (complement is free to attack the RBCs because no antibody–antigen complex formed).
What is in vivo testing?
It is similar to serological testing, but an antigen or antibody is introduced into a patient to elicit some sort of visible reaction (welt or inflammation)
Ex.
- Tuberculin reaction:
- A small amount of purified protein derivative from Mycobacterium tuberculosis is injected into the skin
- The appearance of a red, raised, thickened lesion indicates previous exposure to tuberculosis
What is specificity?
- The property of a test to focus on only a certain antibody or antigen. This means it can bind to ONE antigen.
- Does not react with unrelated or distantly related antigens
- Antibodies are specific to the antigen
A test with high specificity will have _________.
Low false positives (no positive test unless the exact antigen-antibody complex is present).
What is sensitivity?
- The detection of even minute (very small) quantities of antibodies or antigens in a specimen
- I can "feel the energy" even with a small amount.
A test with high sensitivity will have _____________.
low false-negative rate
- even if there is only one virus, the test can pick it up.
- Low false negative rate means the test is very unlikely to miss someone who actually has the infection.
- Because the test can detect even tiny amounts of antigen or antibody, if you test positive, you can be confident that you do have or had that disease/microbe.
- In other words, the test rarely says “negative” when you’re actually positive.
What are the three types of genotypic testing?
Anything dealing with nucleic acids!
WHY N?
1. Nucleic acid amplification tests: using primers to amplify specific DNA sequences. (PCR, TMA, other NAAT)
2. Hybridization: FISH (in situ)
3. Whole-genome sequencing: high-throughout methods have made whole-genome sequencing widely accessible.
What is PCR?
- Results in the production of numerous copies of DNA or RNA molecules within hours
- Very sensitive, even amplify small amounts of nucleic acids in sample.
- Can amplify minute quantities of nucleic acids in a sample, greatly improving the sensitivity of diagnostic tests
- Can be performed on bacteria, viruses, protozoa, and fungi
- the purpose of amplification in PCR is to make millions of copies of a specific DNA segment so it can be easily detected, studied, or analyzed.
- Often, the amount of DNA in a sample is too tiny to test directly.
- By amplifying it, you increase the signal, making it possible to detect the microbe, study genes, or run further tests.
What does PCR require?
- Template DNA: The DNA you want to copy (from the microbe or sample).
- Primers: Short single-stranded DNA sequences that are complementary to the ends of the target region; they define what gets amplified.
- DNA polymerase: An enzyme (usually Taq polymerase) that synthesizes new DNA strands.
- Nucleotides (dNTPs): The building blocks (A, T, G, C) used to make new DNA.
- Buffer and ions: Maintain the optimal chemical environment for the polymerase to work.
- Thermal cycler: A machine that cycles through different temperatures to allow denaturation, primer annealing, and extension repeatedly
What are the different types of PCR?
1. Real-Time PCR (qPCR)
- Measures DNA amplification as it happens using fluorescent labels.
- Tells you how much DNA is present, not just if it’s there.
- Key: quantitative + real-time tracking.
- Fluorescent probes (like TaqMan) → bind only to the target DNA sequence.
- During amplification:
- As PCR copies DNA, more double-stranded DNA or target sequences are made.
- The fluorescent dye/probe binds to the DNA, and the signal increases
2. Reverse-Transcriptase PCR (RT-PCR)
- Converts RNA → cDNA first, then amplifies it.
- Used for RNA viruses or gene expression studies.
- Key: lets PCR work on RNA templates.
3. Multiplex PCR
- Uses multiple primers in one reaction to detect several organisms at once.
- Great for differential diagnosis — you can check for multiple pathogens in the same sample.
- Key: one sample, many targets.
4. Panbacterial qPCR
- Uses a primer common to all bacteria to detect the total bacterial load in a sample.
- Good for studying microbiota or broad bacterial screening.
- Key: universal bacterial detection.
What is hybridization?
- Makes it possible to identify a microbe by analyzing segments of its genetic material
- Probes: Small fragments of DNA or RNA known to be complementary to specific sequences of nucleic acid isolated from a particular microbe
- Base-pairing of the probe to the nucleic acid can provide evidence of the microbe’s identity
- The probe often has a label (radioactive, fluorescent, or colorimetric), so binding produces a signal.
What is FISH?
- Application of fluorescently labeled probes to intact cells within a patient specimen or environmental sample
- Used to locate “glowing cells” and determine the identity of a specific microbe
- Often used to confirm a diagnosis or identify the components of a biofilm
- FISH (Fluorescence In
Situ Hybridization) is a technique that uses fluorescent probes to
detect specific DNA or RNA sequences directly in cells or tissues.
Here’s the breakdown in simple terms: How FISH
works:
- Probe design:
- A fluorescently labeled DNA or RNA probe is made to match a specific sequence of the microbe or gene of interest.
- Hybridization:
- The probe is added to a fixed sample of cells or tissue.
- It binds (hybridizes) to its complementary nucleic acid inside the cell.
- Detection:
- Under a fluorescence microscope, the bound probe lights up, showing exactly where the target DNA or RNA is located.
- “In situ” = in its natural location (inside cells or tissue).
- Can be used for microbes, genes, or chromosomal abnormalities.
- Highly specific because it relies on base-pairing of the probe.
- Probe design:
What is the difference between FISH and hybridization?
Regular hybridization:
- Usually done in solution or on a membrane (like a blot).
- Detects whether a specific nucleic acid sequence is present in the sample.
- Doesn’t show where the target is in a cell or tissue — just that it exists.
FISH (Fluorescence In Situ Hybridization):
- Done “in situ”, meaning inside intact cells or tissues.
- Detects both the presence and the exact location of the target sequence.
- Uses fluorescent probes to visualize under a microscope.
Name two examples of techniques that employ hybridization.
- Southern Blot – detects specific DNA sequences in a sample using a labeled DNA probe.
- FISH (Fluorescence In Situ Hybridization) – detects DNA or RNA sequences inside intact cells or tissues using fluorescent probes.
What are the materials required for FISH?
- Sample:
- Cells, tissue sections, or microbial samples fixed on a slide.
- Probe:
- Fluorescently labeled DNA or RNA that is complementary to the target sequence.
- Hybridization
buffer/solution:
- Maintains optimal conditions for probe binding.
- Fixatives:
- Chemicals like formaldehyde or paraformaldehyde to preserve cell/tissue structure.
- Washing solutions:
- Remove unbound probes after hybridization to reduce background signal.
- Microscope:
- A fluorescence microscope to visualize the fluorescent signal.
What is whole genome sequencing?
- Useful for rapid analysis of outbreaks and drug-resistant organisms
- Low cost
- Deep sequencing: A single genome can be scanned and analyzed multiple times with fewer errors
What is a microarray?
What they are:
- Microarrays are tiny “chips” or plates with thousands of known gene sequences from different microbes (bacteria, viruses, fungi).
- The sequences are selected based on the disease or syndrome you’re investigating.
How they work:
- Prepare patient sample:
- Extract DNA or RNA from the patient.
- Hybridization:
- The patient’s nucleic acids are added to the microarray.
- If a patient’s sequence matches a sequence on the chip, it will bind (hybridize).
- Detection:
- The probe sequences on the chip are fluorescently labeled.
- A computer reads the fluorescence pattern to identify which microbes are present in the sample.
Main use:
- Allows simultaneous detection of thousands of pathogens in one test.
- Helps diagnose infections based on syndrome rather than testing for one microbe at a time.
Chapter 12
Antimicrobial Treatment
What is the goal of antimicrobial therapy?
Administer a drug to an infected person that destroys the INFECTIOUS agent without harming the host cells!
What are some characteristics to the ideal antimicrobial drug
- Toxic to the microbe
- Non-toxic to host (does not disrupt host healthy by allergies or making them likely to other infections)
- Microbicidal (kills) rather than Microbiostatic (stops or slows growth, but not kills)
- Soluble in body fluids
- Long-lasting half life (to act and is not excreted early)
- nonexistent or slow development of antimicrobial resistance
- Complements/helps host's defenses
- Active in tissues and body fluids
- Delivered to SITE OF ACTION
What is prophylaxis?
Use of a drug to prevent imminent infection of a person at high risk
Prophylaxis means preventing a disease before it happens
What is antimicrobial chemotherapy?
The use of drugs to control infection (specifically chemicals)
What is antimicrobials?
All-inclusive term for any antimicrobial drug, regardless of what type of microorganism it targets
Antibiotics can be produced ________ or created ___________.
by the natural metabolic processes (natural sources) of some microorganisms or created by scientists.
What's more effective: semisynthetic drugs or synthetic drugs?
- Natural drugs come straight from living organisms (like penicillin from mold).
- Semisynthetic drugs are natural drugs that have been chemically modified to improve their properties — like making them more stable, broader in spectrum, or less likely to cause resistance.
- Synthetic drugs are completely made in the lab, designed to target specific microbial processes.
What's the difference between narrow-spectrum and broad-spectrum antimicrobials?
- Narrow-spectrum (limited spectrum): Antimicrobials effective against a limited array of microbial types—for example, a drug effective mainly on gram-positive bacteria
- Broad-spectrum (extended spectrum): Antimicrobials effective against a wide variety of microbial types—for example, a drug effective against both gram-positive and gram-negative bacteria
What is the most common origin of antimicrobial drugs?
Antibiotics are common metabolic products of bacteria and fungi.
- Inhibiting the growth of other microorganisms in the same habitat reduces competition for nutrients and space
- Some bacteria and fungi naturally make antibiotics as part of their normal metabolism — basically, it’s how they compete and survive in their environment.
- These microbes produce antibiotic substances to kill or inhibit the growth of other microbes around them, so they can have more nutrients and space.
What are the three factors that must be known before starting antimicrobial treat?
1. What is the identity of the microorganism? - many methods
2. What is the microorganism's susceptibility to various drugs? (can it be harmed or hindered)
3. How does the patient react to the drug?
What is the Kirby-Bauer Technique?
The Kirby-Bauer test measures how well an antibiotic can stop bacterial growth. Small discs containing antibiotics (pre-measured amount) are placed on a plate with bacteria (special medium), and the drug spreads outward. If the antibiotic works, it creates a zone of inhibition (edge to edge of no growth) — a clear area where bacteria can’t grow. The size of this zone shows how sensitive or resistant the bacteria are to that antibiotic. It will then be compared with the standard for each drug, determining if its sensitive or resistant or in the middle.
What is the Etest?
It's an alternative to Kirby-Bauer. The E-test is used to determine the minimum inhibitory concentration (MIC) — the smallest amount of an antibiotic needed to stop bacterial growth. A plastic strip with a predefined gradient of antibiotic concentrations is placed on an agar plate that has been spread with bacteria. As the antibiotic diffuses from the strip, it creates zones where bacteria cannot grow. The point where bacterial growth stops along the strip shows the MIC value, indicating how sensitive the bacteria are to that antibiotic.
From bottom to top, the concentration of antibiotic increases as you go up the strip.
Instead of a perfect circle around a disc, the E-test creates an elliptical (oval-shaped) zone of inhibition that follows the antibiotic gradient on the strip. The point where the edge of bacterial growth meets the strip marks the minimum inhibitory concentration (MIC) — the lowest antibiotic concentration that prevents growth.
What's the difference between E-test and Kirby-Bauer?
- Kirby-Bauer → circular zone → measures general susceptibility
- E-test → elliptical zone → measures exact MIC value
What's the purpose of an MIC?
- Useful in determining the smallest effective dosage of a drug
- Provides a comparative index against other antimicrobials
What is the tube dilution test?

The tube dilution test is used to determine the minimum inhibitory concentration (MIC) — the lowest concentration of an antibiotic that prevents bacterial growth.
Here’s how it works:
- A series of test tubes are prepared with the same amount of bacteria but increasing concentrations of the antibiotic (for example: 0, 20, 40, 60 µg/mL, etc.).
- The tubes are then incubated to allow bacterial growth.
- After incubation, you check for turbidity (cloudiness = bacterial growth).
- The first clear tube (no turbidity, sometimes shown as blue instead of pink) indicates that the bacteria stopped growing — that concentration is the MIC.
So basically:
- Cloudy = growth (bacteria resistant)
- Clear = no growth (bacteria inhibited)
- The lowest clear tube = the MIC value
Why might an antimicrobial treatment fail?
- It didn't get to the site of the infection
- Resistant microbes
- An infection may be caused by one or more pathogen, some which may be resistant
What is the Therapeutic index (TI)?

The ratio of the dose of the drug that is toxic to humans to its effective dose. The therapeutic index (TI) measures a drug’s safety margin — it’s the ratio between the toxic dose and the effective dose. A high TI means the drug is safer (there’s a big gap between helpful and harmful doses), while a low TI means it’s riskier because the effective and toxic doses are close together. TI of 1.1 is riskier than TI of 10.
What is therapeutic window?
- The range of blood level of the drug in which it is producing the desired effect without toxicity
True or False: So, the lower the therapeutic index, the greater the margin of safety for that drug.

FALSE, it should be higher...
So, the higher the therapeutic index, the greater the margin of safety for that drug.
What is selective toxicity?
- Antimicrobial treatment drugs should kill or inhibit ONLY microbial cells without also damaging host tissues. Best drugs block actions or synthesis of microbes but not vertebrae cells.
Ex. peniciliin - excellent selective toxicity, only blocks synthesis of cell wall in bacteria.
What are the main 5 different mechanisms of metabolic targets on therapeutic agents?
1. Inhibition of cell wall synthesis
2. Inhibition of nucleic acid structure and function
3. Inhibition of protein synthesis, involving mainly ribosomes
4. Interfering with cell membrane structure or function
5. Inhibition of folic acid synthesis
Why is folic acid important to microbes?
Folic acid (vitamin B₉) is super important to microbes because it’s essential for making DNA, RNA, and amino acids
- Folic acid helps make nucleotides, the building blocks of DNA and RNA.
- Microbes can’t get folic acid from their environment (unlike humans who get it from food), so they have to synthesize it themselves.
- Because of that, antibiotics like sulfonamides (sulfa drugs) target the enzymes microbes use to make folic acid — stopping their growth without harming human cells.
Primary sites of antimicrobial treatment on bacterial cells!

What are the three main effects or side effects of antimicrobials?
1. Toxicity to human organs
2. Human Allergic response to drugs (drugs can act as antigens) - Penicillin, then Sulfonamides
3. Altercation or Supression of Human Microbiota
What is superinfection?
After an antimicrobial destroys beneficial resident species, other microbes that were once in small numbers can begin to overgrow and cause disease
Ex.
- Vaginal yeast infection (by Candida albicans) after antibiotic treatment
- Antibiotic-associated colitis due to the overgrowth of Clostridioides difficile after antibiotic treatment
a superinfection happens when antibiotics kill off the normal, helpful microbes in your body — like the ones in your gut or on your skin — and this gives opportunistic pathogens (like Candida or C. difficile) a chance to overgrow.
Basically, the antibiotic wipes out the good guys, and the bad ones take over, causing a new infection on top of the original one you were treating. oth Candida albicans (a yeast) and Clostridioides difficile (a bacterium) normally live in small amounts in your body — Candida in places like your mouth, gut, and vagina, and C. difficile in your intestines.
They usually don’t cause problems because your normal microbiota keep them in check. But when antibiotics kill off that good bacteria balance, these guys can overgrow — leading to infections
What is the main example of broad-spectrum drugs?
- Effective against more than one group of bacteria
- Example: tetracyclines
What are the two examples of narrow-spectrum drugs? (PP)
- Only target a specific group
- Examples: polymyxin and penicillin
What are the drugs targeting the cell wall? (PVCC)

1. Penicillin
- B-Lactams are large/diverse group of antibiotics
- The β-lactam ring binds to enzymes (called penicillin-binding proteins, or PBPs) that bacteria use to build their cell wall. When the ring binds to those enzymes, it blocks them from forming cross-links in the peptidoglycan layer (the strong mesh that gives bacterial cells structure). Without those cross-links, the bacterial cell wall becomes weak and leaky, so the cell eventually bursts (lyses) — especially when it takes in water through osmosis
- Naturally or synthesized in lab
- Three parts: B-lactam ring, thiazolidine ring, variable side chain
2. Cephalosporin (used when penicillin is not effective)
- Isolated from Cephalosporium acremonium
- B-lactam ring that can be synthetically altered
- Similar mode of action to penicillins
3. Carbapenem
- Reserved for use in hospitals when other drugs do not work (due to major antibiotic resistance)
4. Other miscellaneous drugs
- Bacitracin, Isoniazid (mycobacterium tuberculosis), vancomyocin
What is clavulanic acid, and what is it mechanism of action?
Inhibits β-lactamase enzymes and is added to other penicillins to increase their effectiveness in the presence of penicillinase-producing bacteria
Some bacteria make an enzyme called β-lactamase (or penicillinase), which basically destroys the β-lactam ring in penicillin and makes the antibiotic useless.
To stop that, scientists created β-lactamase inhibitors (like clavulanic acid). These inhibitors are added to penicillins — for example, in Augmentin (amoxicillin + clavulanic acid).
The inhibitor’s job is to bind to and block the β-lactamase enzyme, so the enzyme can’t destroy the penicillin. That way, the antibiotic can still attack the bacterial cell wall effectively
What is vancomyocin, and what is the mechanism of action?
Targets the Cell Wall
- Narrow spectrum of action
- Used to treat staphylococcal infections in cases of penicillin and methicillin resistance or in patients with an allergy to penicillin
- Vancomycin binds directly to the amino acid chain (D-Ala-D-Ala) on the peptidoglycan subunits themselves.
- This physically blocks the enzymes from linking those subunits together — imagine it grabbing the building blocks and saying, “nope, you’re not getting glued today.”
- Without proper cross-linking, the cell wall stays weak, and the bacteria eventually bursts (lyses) due to osmotic pressure.
What are the drugs targeting protein synthesis (impairs prokaryotic ribosomal function)?

1. Aminoglycosides = "awful translation)
- 6-carbon ring attached to one or more sugar
- Product of actinomycetes: streptomyces and micromonospora
- BROAD spectrum
- Cause misreading of mRNA, affect the 30S, resulting protein is non-functional in bacteria.
- They bind irreversibly to the 30S ribosomal subunit, which is the part that helps read mRNA and match tRNAs correctly. This binding causes misreading of the mRNA code, so the ribosome adds the wrong amino acids to the growing protein chain. The result? Defective, nonfunctional, or toxic proteins that can kill the bacterial cell.
2. Oxazolidinoes
- Synthetic Drugs
- Prevent initiation and block ribosome assembly (binds to 50S and keeps both subunits from coming together)
- MSRA and VRE (antibiotic resistant organisms)
3. Pleuromutilins
- Block peptidyl transferase
- Formation of peptide bonds is blocked, and it prevents elongation, so you have a truncated protein.
- External skin application only
4. Tetracyclines/Glycacyclines
- Blocks the A site for tRNA, so it cannot come in and bring more amino acids for elongation. No protein is synthesized.
- Derived from streptomyces
- Natural compound or synthetic
- Broad-spectrum
- They bind to the 30S ribosomal subunit, right where the A site (aminoacyl site) is located. The A site is where new tRNA molecules normally come in carrying amino acids. By blocking the A site, tetracyclines prevent tRNA from binding—so no new amino acids can be added to the growing protein chain. Translation basically stalls, and the bacteria can’t make proteins needed to survive.
5. Macrolides
- Broad-spectrum and low toxicity
- Lactone ring with sugars attached
- Mostly semisynthetic
- Middle ear, respiratory, and skin infections
- Bind to the 50S ribosomal subunit of bacteria. This blocks the exit tunnel through which the growing protein chain normally leaves the ribosome. As a result, protein elongation stops, and the bacteria can’t make essential proteins. Because protein synthesis is halted, the bacteria stop growing (bacteriostatic) or sometimes die (bactericidal, depending on the drug and concentration).
What is streptomycin?
Inhibits proper protein synthesis
- Aminoglycoside
- Insert on sites on the 30S subunit and cause the misreading of the mRNA, leading to abnormal proteins
- Broad-spectrum; used to treat infections caused by gram-negative rods, certain gram-positive bacteria
-
used to treat bubonic plague, tularemia,
and tuberculosis
What is erythromycin?
Macrolide Antibiotic - inhibits protein synthesis as it inhibits translocation of subunit during translation
- Can be used to treat mycobacterium infections in AIDS patients
- During translation, the ribosome moves along the mRNA in a process called translocation.
- After a new amino acid is added, the tRNA in the A site moves to the P site, and the ribosome shifts along the mRNA so the next codon can be read.
- Some antibiotics (like macrolides and lincosamides) bind to the 50S subunit and block this movement.
- If the ribosome can’t translocate, no new amino acids are added, and protein synthesis stops.
What are antibacterial drugs targeting folic acid synthesis?
They prevent proper metabolism, preventing microbes from replicating, then not allowing them to make proteins, and this class can be used with other drugs.
- Sulfa drugs or sulfonaminds
- Sulfisoxazole: treat acute UTI and certain protozoan infections
- Silver sulfadiazine: prescribed for treatment of burns
- Trimethoprim: may be given in combination with sulfamethoxazole
- Sulfamethoxazole and Trimethoprim: Interfere with folate metabolism by blocking enzymes required for the synthesis of tetrahydrofolate, which is needed by the cells for folic acid synthesis and eventual production of DNA, RNA, and amino acids. Treatment of UTI and protozoan infections
What are the antibacterial drugs targeting DNA or RNA?
1. Fluoroquinones (Ciprofloxacin, Levofloxacin, Nalidxic Acid, Trovafloxacin)
- Broad spectrum
- High potency
- Absorbed from intestine
- Inhibits helicase, so prevents unwinding of DNA (blocks replication and transcription)
2. Ansamycin
- Ex. Rifampin
- Limited spectrum
- Mainly treats gram + and few gram - (as it cannot pass through cell envelope well)
- Leprosy and Tuberculosis
- Inhibits the initiation of transcription of DNA (@DNA level, block DNA/RNA polymerase from binding)
What are the antibacterial drugs targeting cell membranes?
1. Polymyxins
- Bacillus polymyxa
- Narrow-spectrum
- fatty-acid component allows for detergent activity, pokes holes in membrane causing leaking outside of bacteria cell, leading to lysis and death
- TOXIC to kidneys (last-resort)
- Interact with membrane phospholipids; distort the cell surface and cause leakage of protein and nitrogen bases, particularly in gram-negative bacteria
- Treat drug-resistant pseudomonas and severe UTIs caused by gram-
- Polymyxin B and E
- Daptomycin (subgroup)
What is daptomycin?
- Type of polymxin (disrupts cell membrane)
- Lipopeptide made by Streptomyces
- Most ACTIVE against gram+ bacteria
- Can treat biofilms
What are three treatments for quorom-sensing pathways?
- Bacteria in biofilms (like on catheters, teeth, or medical implants) are much harder to kill—up to 1,000× more resistant—than the same bacteria floating freely in liquid (planktonic form).
- This happens because biofilm bacteria express different
phenotypes:
- They produce a protective matrix (slime layer) that blocks antibiotics.
- They slow their metabolism, making antibiotics that target growing cells less effective.
- They can communicate and cooperate, sharing resistance genes.
1. Interrupt quorum-sensing pathways
2. Daptomycin
3. Pretreatment
Which of the following are treatments for helminths?
- Albendazole
- Pyrantel
- Metronizadole
- Praziquantel
- Ivermectin
- Pyrantel (inhibits round worms by paralyzing their muscles not allowing them to grab onto intestines of host)
- Everything but metronidazole, which is for protozoa
What are three major modes of action for antiviral agents? - MPM
STOP penetration (virus into host cell), multiplication (replication, transcription, translation of viral molecules), and maturation of viral particles
Explain the inhibition of virus entry?

Receptor/Fusion/Uncoating Inhibitors
- Enfuvirtide (Fuzeon) - BLOCKS HIV infection by preventing binding of viral receptors to cell receptors and preventing fusion
- Amatadine and its relatives such as zanamivir, oseltamivir - interfering with fusion of virus with cell membrane and release and stop action of virus into cell for assembling
Explain inhibition of nucleic acid synthesis? (RR)

- Analogs are used, such as fake nucleotides, that mess with the DNA structure and inhibit proper binding of key molecules (prevent synthesis, etc.)
1. Remdesivir - purine analogs that terminate RNA replication in COVID
2. Ribavirin - purine analongs, used for hep C.
Explain inhibition of nucleic acid synthesis without nucleotide analongs?

Non-nucleotide analogs are drugs that look similar to the natural building blocks (nucleotides) of DNA, but they aren’t real nucleotides.
- For HIV, these drugs target reverse transcriptase (RT) — the enzyme that turns viral RNA into DNA.
- The fake nucleotide gets in the way: the enzyme can’t properly bind or use it, so DNA synthesis stops.
- Example: AZT (zidovudine) — it mimics a nucleotide, but once incorporated, it prevents the viral DNA chain from growing, blocking HIV replication.
Explain inhibition of viral assembly or release?

This prevents a mature virion from forming or being released.
Ex. Indinavir and Saquinavir
Protease inhibitors; insert into HIV protease, stopping its action and resulting in inactive noninfectious viruses -
- HIV protease is an enzyme the virus needs to cut long viral protein chains into functional pieces that form new, infectious virus particles.
- Protease inhibitors are drugs that fit into the protease enzyme’s active site, like a key in a lock, but block its action.
- Without protease activity, the virus can’t properly assemble its proteins, so the new virus particles are malformed and noninfectious.
- Result: the virus can’t spread effectively to infect new cells.
What is antibiotic resistance?
- Adaptive response in which microorganisms begin to tolerate an amount of drug that would ordinarily be inhibitory (adapt to the drug so the drug cannot inhibit and the microbe can grow)
What is the difference between intrinsic vs. acquired resistance?
- Intrinsic: bacteria must be resistant to any antibiotic that they themselves produce
- Some bacteria naturally make antibiotics to kill other microbes. To avoid killing themselves, these bacteria have built-in (intrinsic) resistance to their own antibiotic.
- Example: Streptomyces species produce streptomycin, but they have mechanisms to protect themselves from being affected by it.
- Avoid poisoning yourself.
_______________________________
- Acquired: bacterial resistance to a drug to which they were previously sensitive
What are the different ways to acquire antimicrobial resistance?

1. Mutation
- Permeability or uptake of drug into bacteria is decreased, could be due to new shaped receptor from mutation
2. Horizontal Transfer - GAIN new genes
- Plasmids can be transferred through C, T, and T
- Transposons: duplicated and inserted sequences from one plasmid to another
- Rapid proliferation of drug-resistant species
3. New enzymes synthesized to inactivate the drug (occurs when new genes are acquired)
4. Drug is eliminated (through new genes which add pumps or transporters)
5. Binding sites can be decreased in number or affinity (due to new genes)
6. A new or alternative pathway the drug can act (due to mutations of original enzymes)
True or False:
Any large population of microbes is likely to contain a few individual cells that are naturally drug resistant

True
- If the drug is not present in the population, the number of these resistant forms will remain low
- If the population is exposed to the drug, sensitive individuals will be killed, and the resistant forms will remain
What are probiotics?
Preparations of live microorganisms fed to animals and humans to improve intestinal biota
GIVES actual bacteria
- Replace lost microbes
- Supplement biota
Safe and effective
What are prebiotics?
- Gives bacteria food
- Nutrients that encourage the growth of beneficial microbes in the intestine
- Feeds nutrients to the resident microbiota to encourage growth
What's the main difference between probiotics and prebiotics
- Probiotics = live beneficial bacteria you consume to help balance your gut microbiota (e.g., yogurt with Lactobacillus).
- Prebiotics = non-digestible food components (usually fibers) that feed the good bacteria already in your gut, helping them grow and thrive (e.g., inulin in onions or garlic).
Chapter 20
Infectious Diseases Manifesting in the Nervous System
Describe the anatomy of the brain and spinal cord.
The brain and spinal cord is made up of neurons and surrounded by neurons. Brain is inside skull and spinal cord is inside the spinal column.
Brain is surrounded by the meninges: (outside to inside) - Dura mater, arachnoid mater, and pia mater
The CSF fills the _________, and is generally _____ in color.
What are the two functions of the CSF?
Subarachnoid space
clear, serum-like
Provides liquid cushion for brain and spinal cord and provides nutrients to CNS
What are the structural defenses of the nervous system?
- Bony casings of brain and spinal cord
- CSF serves as cushion against impact
- BBB (filter medications and microbes)
What is the blood-brain barrier?
Cells that make up the walls of the blood vessels around the brain allow FEW molecules to pass (freer passage of ions, sugars, other metabolites)
- PROHIBITS most microbes
- HARD to introduce drugs and antibiotics to CNS
- SELECTIVE
True or False: There is NO immune privilege of the CNS.
False
- CNS has a different or partial immune response when exposed to immunologic challenge
- Functions in the CNS are vital for life, and the normal CNS can cause temporary damage
- Cells in the CNS have lower levels of MHC antigens and complement proteins
What two specialized cells in the CNS provide defenses to the body?
Microglial cells show phagocytic activity
- Brain macrophages
- Phagocytic activity is still LESS than other phagocytic cells in the body.
True or False:
- Certain viruses live in a dormant state in the nervous system between episodes of acute disease
- Example: herpes simplex viruses
- This is considered part of the normal microbiota.
FALSE
True or False:
There is no normal microbiota of the CNS and PNS.
True
What is the gut-brain axis?
Recent microbiome studies reveal a relationship or potiental link between the gut microbiome and nervous system as gut microbiota may induce CNS autoimmunity and can cause changes in brain chemistry and behavior.
What is meningitis?
Inflammation of the meninges
- Different microbes cause meningitis and produce a similar constellation of syndromes (bacteria, virus, or fungi)
- Noninfectious causes of meningitis exist as well but are less common (trauma, cancer, autoimmune disorder)
- Serious forms of acute meningitis are caused by bacteria
- Entrance into CNS is facilitated by co-infection or previous infection with respiratory viruses
- Acute or Chronic disease
7 Different Types
What can you do when you suspect someone has meningitis?
Obtain CSF through a lumbar puncture
Gram stain and/or culture of CSF
- A Gram stain is done to see bacteria under the microscope and get a quick idea of the type (Gram-positive or Gram-negative).
- A culture grows any bacteria present so they can be identified and tested for antibiotic sensitivity.
Begin treatment with broad-spectrum antibiotics immediately (then shift treatment after confirmation of diagnosis)
What are the typical symptoms of meningitis? (generally the same regardless of the cause)
- Photophobia
- Headache
- Painful or stiff neck
- Fever
- Increased WBC in CSF
- Certain microorganisms may cause additional characteristic symptoms
True or False: In a healthy person, the blood-brain barrier and other defenses usually prevent microbes from entering the nervous system, so infections like meningitis are rare unless the barriers are compromised.
True
- Successful microorganisms have specific virulence factors
What is a conjugated vaccine?
Weak antigen (like a bacterial capsule made of sugar) is attached—or “conjugated”—to a strong protein antigen to make it more visible to the immune system.)
- Some bacteria (like Neisseria meningitidis or Haemophilus influenzae type b) have sugar capsules that don’t trigger a strong immune response, especially in young kids.
- By linking that sugar to a protein, the immune system recognizes it better and makes strong, long-lasting antibodies.
Which of the causative agents of meningitis have a vaccine for prevention?
Neiserria meningitdis, Streptococcus Pneumoniae, Haeomphilus Influenzae.
Neisseria meningitidis causes what, and what information is relevant?

- Gram Negative Diplococci
- Also known as meningococcus
- Associated with epidemic forms
- Meningococcemia: also gets in the blood stream on top of the brain and spinal cord (RARE, high mortality rate)
- Endotoxin acts as a potent WBC stimulator
- Damage to blood vessels caused by cytokines released by WBC leads to vascular collapse, hemorrhage, and crops of red or purple lesions called petechiae on the trunk and appendages
Mode of Transmission: DROPLET
Virulence Factors:
- Endotoxin: (lipooligosaccharide) that triggers a strong inflammatory response in the body, which can lead to fever, shock, and damage to blood vessels.
- Capsule: The bacterium has a polysaccharide capsule that protects it from being engulfed and destroyed by phagocytic immune cells, allowing it to survive and spread within the bloodstream.
- IgA protease: Neisseria meningitidis produces an IgA protease enzyme that breaks down immunoglobulin A (IgA) antibodies on mucosal surfaces, helping the pathogen evade the immune system and colonize the nasopharynx.
Culture/Diagnosis: gram stain/culture of CSF, blood/rapid antigenic test, oxidase test, PCR
Prevention: Conjugated vaccine, ciprofloxacin, rifampin, or ceftriaxone to protect contacts (CRC)
Treatment: Ceftriaxone and Penicillin
Distinctive features: petechiae, meningococcemia, rapid decline
Epidemiological Features: 14% of bacterial meningitis; increasing in men having sex with men; meningitis belt: 1,000 cases per 100,000 annually
How does neisseria meningitdis use the oxidase test?

Neisseria meningitidis is oxidase-positive, and the oxidase test helps confirm that.
Here’s how it works:
- The oxidase test detects if the bacterium produces the enzyme cytochrome c oxidase, part of its electron transport chain.
- When a reagent (like tetramethyl-p-phenylenediamine) is added, it turns dark purple if the enzyme is present.
- Since Neisseria meningitidis has this enzyme, the color change appears, showing it’s oxidase-positive ✅
What causative agent causes the most serious form for of acute meningitis?

Neisseria Meningitdis
*14% of all cases
What causative agent is the most frequent cause of CAM (community-acquired meningitis) and bacterial meningitis?
Streptococcus pneumoniae.
Streptococcus pneumoniae causes what, and what information is relevant?

- Also known as Pneumococcus
- Small Gram Positive
- Flattened coccus, end-to-end pairs
- No petechiae
- Most likely to occur in patients with underlying susceptibility.
Mode of Transmission: DROPLET
Virulence Factors:
- Capsule: polysaccharide capsule which protects against phagocytosis
- Induction of apoptosis: S. pneumoniae can trigger programmed cell death (apoptosis) in host cells, including immune cells, which weakens the body’s defense response and helps the infection progress.
- Hemolysin: produces an alpha-hemolysin which induces damage to CNS. This toxin damages host tissues, including the cells of the central nervous system (CNS). It contributes to inflammation and tissue injury during infections like meningitis.
- Hydrogen Peroxide Production - The bacteria produce hydrogen peroxide as a byproduct, which can damage host cells and contribute to tissue injury in the CNS, worsening symptoms during infection.
Culture/Diagnosis: Gram stain/culture of CSF (distinct appearance on gram stain of CSF)
Prevention: TWO vaccines
Treatment: Vancomyocin + ceftriaxone or cefotaxime (resistant S. pneumoniae is serious threat)
Distinctive features: Serious, acute, most common meningitis in adults
Epidemiological Features: Most common cause of bacterial meningitis in the United States (58% of cases)
What two products of S. pneumoniae further act as the virulence factors for meningitis?
Alpha hemolysis
Hydrogen Peroxide
Haemophilus influenzae causes what, and what information is relevant?

- Gram Negative Coccobacillus
- One of the most severe forms of meningitis in humans
- Often called "Hib" because serotype is most common cause of infection
- Vaccine - reduced asymptomatic carriage rates
Mode of Transmission: DROPLET
Virulence Factors: Capsule
Culture/Diagnosis: culture on chocolate agar
Prevention: HiB vaccine, ciprofloxacin, rifampin, ceftriaxone (CPC)
Treatment: Ceftriaxone
Distinctive features: Serious, acute, less common since vaccine was made
Epidemiological Features: HIA now becoming common in North America; before Hib vaccine, 300,000–400,000 deaths worldwide per year from b serotype
Which causative agent can cross the placenta and cause premature abortion and fetal death?
Listeria monocytogenes
Listeria monocytogenes causes what, and what information is relevant?

- Gram-Positive (ranges in shape from coccobacilli to long filaments in palisade formation)
- NO capsule or endospores
- 1-4 flagella
- Not fastidious, resistant to cold, heat, salt, pH extremes, and bile
- Grows inside host cells, moves from an infected cell to an adjacent healthy cell
- Listerosis (infected caused by agent). Mild or subclinical in healthy adults. Fever, diarrhea, sore thraot
- Affects brain and meninges, resulting in septicemia in elderly, immuno, fetuses, and neonates
- Death rate - 20%
- Associated with contaminated dairy products, poultry, meat
Mode of Transmission: Vehicle (Food)
Virulence Factors: Intracellular growth
Culture/Diagnosis: Cold enrichment, rapid methods
Prevention: Cooking food, avoiding unpasteurized dairy products
Treatment: Ampicillin + gentamicin
Distinctive Features: asymptomatic in healthy people, meningitis in neonates, elderly, and immunocompromised
Epidemiological Features: Mortality as high as 33% in symptomatic cases
What is fastidious mean?

Fastidious means that a microorganism has very specific and complex nutritional or environmental requirements in order to grow.
In other words, fastidious bacteria are “picky eaters” — they need special nutrients, conditions, or growth media that ordinary bacteria don’t.
Cryptococcus neoformans causes what, and what information is relevant?

- FUNGUS - transmitted in bird droppings
- Spherical to ovoid shape with large capsule (tumor-like mass in brain)
- causes chronic meningitis with gradual onset of symptoms
- Those who are immunocompromised, fast onset and acute disease
- Widespread in human habitats
Mode of Transmission: vehicle (air, dust)
Virulence Factors:
- Capsule: This thick polysaccharide capsule protects the fungus from being eaten (phagocytosed) by immune cells like macrophages. It also helps the pathogen avoid detection by the immune system and resist oxidative stress.
- Melanin Production: produces melanin in its cell wall, which protects it from damage caused by the host’s immune defenses (like oxidative bursts) and from environmental stress. Melanin also makes the fungus more resistant to antifungal drugs.
Culture/Diagnosis: Negative staining, biochemical tests, DNA probes, cryptococcal antigen test
Prevention: None
Treatment: Amphotericin B, flucytosine followed by fluconazole
Distinctive Features: Acute or chronic, most common in AIDS patients
Epidemiological Features: In the United States, mainly a concern for HIV+ patients; 90% drop in incidence in the 1990s due to better management of AIDS; worldwide: 1 million new cases per year
Coccidiodes causes what, and what information is relevant?

- "Valley Fever"
- Endemically in natural reservoirs
- Fungus with distinct morphology, and two different strains
- 25C - moist white to brown colony with abundant, branching, septae hyphae
- 37-40C - parasitic phase, small spherule
- True systemic fungal infection, high virulence
- More serious due to genetic susceptibility
- Might form maculopapular rash, starts in lungs (inhale spores), travel to meninges
Mode of Transmission: Vehicle (air, dust, and soil)
Virulence Factors: Granuloma (spherule) formation
- When the fungus enters the body, it forms spherules—large, round structures that contain hundreds of tiny endospores. These spherules are too big for immune cells like macrophages to engulf and destroy. As a result, the immune system walls them off by forming granulomas (clusters of immune cells surrounding the pathogen).
Culture/Diagnosis: Identification of spherules, cultivation on Sabouraud’s agar
Prevention: Avoiding airborne endospores
Treatment: Fluconazole and Amphotericin B
Distinctive Features: exclusively in endemic regions
Epidemiological Features: Incidence in endemic areas: 200–300 annually
Viral meningitis causes what, and what information is relevant?

- wide variety of viruses can cause 4 out of 5 meningitis
- Aseptic meningitis - viral, shows symptoms, but no bacteria/protozoa/fungi in CSF
- Majority of cases in CHILDREN (90% caused by enteroviruses)
- HSV-2, other HHV, and HIV can manifest this
- Milder than bacterial or fungal
- resolved in 2 weeks (self-resolved, can be treated with antivirals)
- Mortality rate is less than 1%
Mode of Transmission: DROPLET
Virulence Factors: lytic infection of host cells
Culture/Diagnosis: Initially, no microbe, followed by viral culture or antigen test
Prevention: N/A
Treatment: None (unless specific virus found and antiviral exists)
Distinctive Features: milder than bacterial or fungal
Epidemiological Features:
In the United States, four of the five meningitis cases caused by viruses; 26,000–42,000 hospitalizations per year
What are some basic facts about neonatal and infant meningitis?
- Usually, a result of infection transmitted by mother in utero or during passes through vertical transfer
- As more premature babies survive, rates of neonatal meningitis increase
- Morbidity have increased, but mortality has decreased
- Most common causes: Streptococcus agalactiae and Escherichia coli
- Listeria monocytogenes is also frequent in neonates (can be found females and adults)
What is the second most common cause of neonatal meningitis?
Escherichia coli
(K1 strain)
Mostly in premature babies
What is the most common cause of neonatal meningitis?
Streptococcus agalactiae
Streptococcus agalactiae causes what, and what information is relevant?

- Group B streptococci (gram +), even though part of normal microbiota
- colonizes 10%-30% of female genital tracts
- MOST frequent cause of neonatal meningitis
- Treated with IV penicillin G, sometimes supplemented with an aminoglycoside
Mode of Transmission: Vertical (during birth)
Virulence Factor: Capsule
Culture/Diagnosis: Culture mother’s genital tract on blood agar; CSF culture of neonate
Prevention: Culture and treatment of mother
Treatment: Penicillin G plus aminoglycosides
Distinctive Features: Most common, positive culture of mother confirms diagnosis
Epidemiological Features: before intrapartum antibiotics in 1996: 1.8 cases per 1,000 live births; after intrapartum antibiotics: 0.32 case per 1,000 live births
Escherichia coli causes what, and what information is relevant?
- Gram Negative Bacteria
- prognosis in premies is poor (20% mortality rate, brain damage for those who survive)
- Transmitted via birth canal
Mode of Transmission: Vertical (during birth)
Virulence Factor: N/A
Culture/Diagnosis: CSF Gram stain/culture
Prevention: N/A
Treatment: Ceftazidime or cefepime and/or gentamicin
Distinctive Features: Suspected if infant is premature
Epidemiological Features: Estimated at 0.2–5 per 1,000 live births; 20% of pregnant women colonized
Listeria monocytogenes causes what, and what information is relevant?
- Listeria can de BOTH adults and neonates
Mode of Transmission: Vertical
Virulence Factor: Intracellular growth
Culture/Diagnosis: Cold enrichment, rapid methods
Prevention: Cooking food, avoiding unpasteurized dairy products
Treatment: Ampicillin, trimethoprim-sulfamethoxazole
Distinctive Features: N/A
Epidemiological Features: Mortality as high as 33% in symptomatic cases
Cronobacter sakazakii causes what, and what information is relevant?
- Found mainly in environments that survive dry conditions
- Implicated in outbreaks of neonatal and infant meningitis through CONTAMINATED formula
- rare cases
- Mortality rate can be 40%
Mode of Transmission: Vehicle (baby formula)
Virulence Factor: ability to survive dry conditions
- Highly resistant outer membrane and protective cellular mechanisms. This ability allows it to persist in formula production and storage areas, increasing the risk of infection when contaminated formula is prepared and consumed.
Culture/Diagnosis: chromogenic differential agar or rapid detection kits
Prevention: Self preparation, use of, or avoidance of powdered formula
Treatment: broad-spectrum antibioitcs until main cause determined
Distinctive Features: N/A
Epidemiological Features: Rare (only handful of cases) but deadly
What are the basic facts regarding meningoencephalitis? (MAN)
Inflammation of the brain (encephalitis) and meningitis - due to close association of the brain and spinal cord, infection of one can cause the other)
Two causative agents are amoebas (protozoa):
1. Naegleria fowleri
2. Acanthamoeba
_______ can enter the subarachnoid space causing ____________ (PAM)?
Naegleria fowleri; primary amoebic meningoencephalitis
- causes rapid, destruction of brain and spinal tissue
- Cases are rare, but the disease advances so rapidly that treatment is futile.
Naegleria fowleri causes what, and what information is relevant?
- Small, flask-shaped ameoba that moves by a single, broad pseudopod
- Round, thick-walled cyst is resistant to temperature extremes and chlorination (natural bodies of waters)
- Typically impacts subarachnoid space
- Infections reported in peole who have been swimming in warm bodies of freshwater
- When a person swims in contaminated lake water, Naegleria fowleri can enter the body through the nose, travel along the olfactory nerve, and reach the brain, where it establishes infection.
Mode of Transmission: Vehicle (exposure while swimming in water)
Virulence Factors: Invasiveness
- The virulence factor “invasiveness” refers to a microbe’s ability to enter, spread, and multiply within host tissues. For an agent like Naegleria fowleri, invasiveness means it can penetrate the nasal mucosa, move along nerve pathways, and invade the brain tissue, causing severe damage as it spreads.
Culture/Diagnosis: Examination of CSF, brain imaging, biopsy
Prevention: limit warm freshwater or untreated tap water from entering nasal passages.
Treatment: Pentamidine, Sulfadiazine
Epidemiological Features: United States: zero to seven cases a year; 97% case fatality rate; spreading to northern states as climate warms
_______ can cause ___________(GAM).
Acanthamoeba; granulomatous amoebic meningoencephalitis
- can cause keratitis and cutaneous ulcers
Acanthamoeba causes what, and what information is relevant?
- Large, amoeboid trophozite with spiny pseudopods and a double-walled cyst
- Invades broken skin, conjuctiva, lungs, and urogenital epithelia
- Course of infection is lengthier than PAM (with 2-3% survival rate)
Mode of Transmission: Direct Contact
Virulence Factors: Invasiveness
Culture/Diagnosis: Examination of CSF, brain imaging, biopsy
Prevention: N/A
Treatment: Surgical excision of granulomas; pentamidine
Epidemiological Features: Predominantly occurs in immunocompromised patients
What are the characteristics of acute encephalitis?
- Almost caused by VIRAL infection, most of the time
- Signs and symptoms: behavior changes or confusion due to inflammation, decreasing consciousness and seizures
- Symptoms of meningitis
- Treated with acyclovir (for HSV caused)
What four pathogens cause acute encephalitis? (HAJI)
1. Arboviruses
2. HSV 1 or 2
3. JC virus
4. Post-infection encephalitis
Arboviruses causes what, and what information is relevant?
- Viruses transmitted by arthropod vectors (mosquitos). Most vectors feed on BLOOD of hosts. Sometimes birds and mammals
- Humans are DEAD-END hosts (we do not allow the life cycle to occur, once we are infected, we cannot pass it down)
- Worldwide distribution
- Clustered in tropics and subtropics; periodic epidemics in temperate zones
- Peak incidence is usually from late spring through early fall
- Warm-blooded hosts maintain the infection during cold and dry seasons (millions of yearly infections and thousands die)
- NO satisfactory treatment
Mode of Transmission: Vector (anthropod bites)
Virulence Factors: (AFI)
- Attachment: The virus has surface proteins that allow it to specifically bind to receptors on host cells, such as neurons or endothelial cells. This is the first step that lets the virus enter and infect the body.
- Fusion: After attaching, the virus can fuse its envelope with the host cell membrane, allowing its genetic material to enter the cell and start infection.
- Invasion Capabilities: Once inside, the virus can spread to different tissues, including crossing the blood-brain barrier to infect the central nervous system—causing inflammation of the brain (encephalitis)
Culture/Diagnosis: history, rapid serological tests, nucleic acids amplication
Prevention: Insect Control
Treatment: NONE
Distinctive Features: history of exposure to insect is important
HSV 1/2 causes what, and what information is relevant?
- HSV 1 and HSV2 can cause encephalitis in newborns of HSV+ mothers
- Virus is disseminated and progress is poor. Virus is disseminated and progress is poor” means that the virus has spread widely throughout the body or brain tissues instead of staying localized. When HSV-1 becomes disseminated, it can cause widespread inflammation and damage in the brain, leading to severe symptoms, complications, and a poorer prognosis (meaning recovery is more difficult and the condition can be life-threatening).
- Older children and young adults (5 to 30) are also susceptible
- Treated with acylovir
Mode of Transmission: Vertical or reactivation of latent infection
Virulence Factors: N/A
Culture/Diagnosis: Clinical presentation, PCR, Ab test, growth of virus in cell culture.
Prevention: Maternal screening for HSV
Treatment: Acyclovir
Distinctive Features: In infants, disseminated disease present (rare between 30-50 years old)
Epidemiological Features: HSV-1 is the most common cause of encephalitis (two cases per million per year)
HSV 1/2 can cause _________ in what populations.
Acute encephalitis;
newborns of HSV+ mothers
Older children and young adults (5-30)
Older Adults (+50)
Which strain of HSV is most common in causing acute encephalitis? What happens that causes it?
HSV-1, represents a reactivation of dormant HSV from the trigeminal ganglion.
What is the most common cause of acute encephalitis?
HSV-1
JV Virus causes what, and what information is relevant?
- Acute Encephalitis
Mode of Transmission:
- Ubiquitous (widespread virus)
- Ubiquitous means the JC virus is found almost everywhere—most people are exposed to it during childhood and carry it in a latent (inactive) state in their kidneys or lymphoid tissues.
Virulence Factors: N/A
Culture/Diagnosis: PCR of cerebrospinal fluid
Prevention: None
Treatment: No effective proven drug, but mefloquine has been used
Distinctive Features: In SEVERELY immuncompromised (AIDS). Most people have this virus as normal microbiota, but when they become immunocompromised, they see the manifestation of this virus.
Epidemiological Features:
For what causative agent is the mode of transmission NOT from person to person — instead, it’s a complication that happens after a previous viral infection or vaccination.
Postinfection encephalitis
- could also be due to overactivation of immune system
Postinfection encephalitis causes what, and what information is relevant?
- Acute Encephalitis
Mode of Transmission: sequelae of measles, other viral infections, occasionally vaccinations
Virulence Factors: N/A
Culture/Diagnosis: History of viral infection or vaccination
Prevention: N/A
Treatment: Steroids, anti-inflammatories
Distinctive Features: Hist of virus/vaccine exposure critical
Epidemiological Features: Rare in the United States due to vaccination; more common in developing countries, more common in boys than girls
What are the three pathogens that cause subacute encephalitis? (PTS not the d unfortunely)
1. Toxoplasma gondii
2. Subacute sclerosing panencephalitis
3. Prions
What causative agent for subacute encephalitis causes the "slow virus infection"
Subacute Sclerosing Panencephalitis (Measles Virus)
What are the basic characteristics for subacute encephalitis?
- Symptoms take longer to show up, and they can be confused with other diagnosis
- Less striking symptoms
- Most common cause is Toxoplasma, and most common (postinfection viral) cause is measles.
What is the difference between subacute and acute encephalitis?

Toxoplasma gondi has two cell types, what are they, and what are they known for?

Tachyzoites and Pseduocysts
Toxoplasma gondii causes what, and what information is relevant?
- Protozoan parasite
- Flagellated, can attach at least 200 species of birds and mammals
- Extensive worldwide distribution
- Majority of the world's population is infected at some point
- When in fetus and immunodeficient people, it's MOST severe and fatal
- People w/ history of Toxoplasma are more likely to display thrill-seeking behaviors (especially with dormant cysts) - and it messes with fear and reward pathways
- Brain inflammation + behavioral change
- Usually asymptomatic, but can have sore throat, lymph node enlargement, and low-grade fever
- chronic or subacute encephalitis in patients with immune suppresion
Mode of Transmission: Vehicle (meat) or fecal-oral
Virulence Factors: intracellular growth
Culture/Diagnosis: serological detection of IgM, culture, and histology
Prevention: personal and food hygiene
Treatment: pyrimethamine and/or leucovorin and/or sulfadiazine
Distinctive Features: subacute, slower development of disease
Epidemiological Features: considered a neglected parasitic infection (NPI)
- 15% to 29% of U.S. population is seropositive; internationally, seroprevalence is up to 90%; disease occurs in 3% to 15% of AIDS patients
What do IgM versus IgG antibodies show?
Here’s why:
- IgM antibodies are the first type of antibody produced by the immune system when the body is first exposed to a pathogen.
- So, if someone’s serum contains anti–Toxoplasma IgM, it shows their immune system is currently responding to the infection or was infected very recently.
- In contrast, if only IgG antibodies are present, it usually indicates a past infection or long-term immunity.
What's the toxoplasma gondii life cycle?
Cats (the definitive hosts) release oocysts in their feces, which sporulate in the environment and can contaminate food or water. When intermediate hosts (like rats, mice, or humans) ingest these oocysts, the parasite travels through the bloodstream and can form cysts in tissues such as the brain and muscles.
Infected rodents show altered behavior (less fear of predators), making them more likely to be eaten by cats — which continues the parasite’s life cycle.
In humans, transplacental transmission can occur if a pregnant person becomes infected, potentially leading to congenital toxoplasmosis, which causes enlarged liver/spleen, hydrocephalus, or stillbirth.
Toxoplasma gondii is very toxic for what human population?
- Pregnant People
- 33% chance of mother transmitting infection to fetus via placenta
Congential infection is in 1st or 2nd trimester
- can lead to stillbirth, liver/spleen enlargement, liver failure, hydrocephalus, convulsions, damage to retina/blindness
What is the primary reservoir (and what type of host) for toxoplasma gondii
Felines, both wild and domestic
Cats serve as the reservoir and definitive host for Toxoplasma gondii because they’re the only animals in which the parasite can complete its sexual life cycle and shed infectious oocysts in their feces.
The modes of transmission to humans are:
- Fecal–oral route: Ingesting oocysts from cat feces, contaminated soil, water, or unwashed produce.
- Foodborne route: Eating undercooked or raw meat containing tissue cysts (especially pork, lamb, or venison).
Subacute sclerosing panencephalitis (persistent measles infection) causes what, and what information is relevant?
- "SLOW VIRUS infection"
- Symptoms appear years after initial episodes of measles
- Caused by DIRECT viral invasion of neural tissue
- Unclear what factors lead to persistence of virus in some people
- In subacute encephalitis caused by measles, even after the initial infection and rash resolve, mutated measles virus or lingering viral RNA can persist in the brain. Over time, it evades the immune system and causes progressive tissue damage, leading to neurological decline.
Mode of Transmission: persistence of measles infection
Virulence Factors: cell fusion, evasion of immune system
Culture/Diagnosis: EEGs, MRI, serology (Ab versus measles virus)
Prevention: None
Treatment: None
Distinctive Features: History of measles
Epidemiological Features: Occurs in one in six people who have recovered from measles
What are culture/diagnosis for the causative agent, SSP? (More info)
EEG
- What it shows: Characteristic periodic, generalized, high-voltage spike-and-slow-wave complexes (often occurring every 4–10 seconds).
- Why that matters: This stereotyped periodic pattern is strongly associated with SSPE and supports the diagnosis when seen in the right clinical setting.
MRI
- What it shows: Asymmetric white-matter changes (T2/FLAIR hyperintensities), cortical atrophy, and later widespread demyelination; lesions often start in the occipital/parietal regions and progress.
- Why that matters: MRI demonstrates the structural brain damage and demyelination expected from a chronic viral process, correlating with the encephalitic and degenerative features of SSPE.
Serology / CSF antibody testing
- What to test: Anti-measles antibodies in serum and especially in CSF.
- Key finding: High measles IgG titers in CSF (and an elevated CSF:serum antibody ratio or evidence of intrathecal antibody synthesis).
- Why that matters: Persistent/intrathecal production of measles antibodies indicates chronic measles virus infection of the CNS rather than just prior exposure — essentially the immunologic proof that measles virus is present in the brain.
True or False: Prions are infectious particles which hold nucleic acids.
False
They are infectious cause they can cause disease but they have no genetic material
How do prions cause disease?
In prion diseases, the normal brain protein (PrPᶜ) is misfolded into an abnormal, infectious form (PrPˢᶜ). This altered protein then induces other normal PrPᶜ proteins to also spontaneously misfold, creating a chain reaction. Over time, the accumulation of PrPˢᶜ proteins forms plaques and causes spongiform (hole-like) damage in the brain tissue, leading to severe neurological symptoms.
- It can also cause disease when transferred to a new host such as contaminated instruments or infected meat.
Prions causes what, and what information is relevant?
- Subacute Encephalitis
- proteinaceous infected particles with NO nucleic acids
- misfolded proteins, they are NOT alive
- Generally, you inherit a mutated form of the prion protein which gets further transformed (for fatal familial insomnia)
- Cause transmissible spongiform encephalopathies in humans
- CJD, Kuru, Fatal familial insomnia (inherited), Gerstmann-Straussler-Schneiker disease
Mode of Transmission:
- CJD = direct/parental contacted with infected tissue or inherited
- vCJD= vehicle (meat or parenteral)
Virulence Factors: avoidance of host immune response
- No immune recognition: Since prions (PrP^Sc) come from the normal cellular prion protein (PrP^C), the body doesn’t recognize them as “non-self.” The immune system is tolerant to these proteins and doesn’t mount an antibody or T-cell response.
- Lack of nucleic acids: Prions don’t have DNA or RNA, so the immune system’s usual viral and bacterial detection mechanisms (which recognize foreign genetic material) don’t detect them.
- Resistance to degradation: Prions are highly resistant to proteases and other enzymes that would normally break down abnormal proteins, so they persist in the body.
Culture/Diagnosis: Biopsy, image of brain
Prevention: Avoiding infected meat or instruments; no prevention from inherited form
Treatment: None
Distinctive Features: Long incubation period; fast progression once it begins
Epidemiological Features: CJD (one case per million worldwide, seen in older adults) and vCJD: 98% of cases in UK
True or False: Zika virus is a DNA virus?
False; RNA virus
What people are cautioned to not travel in Zika-endemic areas? Why?
Pregnant People
- Causes congenital Zika virus syndrome, with microencephaly
- Additional symptoms of the syndrome include vision problems, involuntary movements, seizures, and irritability
Zika virus causes what, and what information is relevant?
- Zika virus
- Transmitted by aedes mosquito bite (via sexual intercourse) and in utero
- When adults are infected, they have a range of symptoms, from none to all: skin rash (maculopapular), conjuctivits, muscle, joint pain, can also trigger Guillain-Barre syndrome in some
Mode of Transmission: Vertical (mother to placenta), vector-borne, sexual contact, possibly blood transfusions
Virulence: proteins that reduces innate immune system response
Culture/Diagnosis: PCR testing
Prevention: avoiding mosquitos, NO VACCINE
Treatment: supportive
Epidemiological: Originated in Africa but spreading throughout world in 2016; small outbreaks in other parts of the world since
What are the basic characteristics for rabies? What are the two types? (FD)
Slow, progressive zoonotic disease characterized by fatal encephalitis
Virus enters the NS and causes involuntary control of muscles
- Furious rabies: agitation, discomfort, seizures, and twitching AND hydrophobia
- Dumb rabies: paralyzed, dis-oriented, and suporous
- Both forms lead to death from cardiac or respiratory arrest as both forms progress to a coma phase.
What are some important aspects of Rabies Prevention and Treatment?
Treatment begins after EXPOSURE and BEFORE symptoms develop
- Passive and active postexposure immunization
- Vaccination of domestic animals, vets, animal handlers, lab, and travelors
- Vaccine incorporated as BAIT to treat wild animals
Rabies viurs causes what, and what information is relevant?

- Structure of virus: glycoprotein spikes, matrix protein, then nucleocapsid
- Reservoir: wild mammals such as skunks, raccoons, badgers, cats, bats, and canines
- Spread to domestic animals and humans through bite, scratches, and inhalation of droplets
- Rabies Preventio
Mode of Transmission: Parenteral (bite trauma) and DROPLET
Virulence: envelope glycoprotein
- The envelope glycoprotein helps rabies cultivate by mediating host cell binding, entry, and spread through the nervous system — making it essential for infection and neuroinvasion.
Culture/Diagnosis: DFA (direct fluorescent antibody test)
Prevention: Inactivated vaccine
Treatment: Postexposure passive and active immunization; induced coma and ventilator if symptoms start
Epidemiological: United States: 1–5 cases per year; Worldwide: 35,000–55,000 cases annually
What is poliomyelitis?
- Acute enteroviral infection of spinal cord which can cause neuromuscular paralysis
- Fever, headache, nausea, sore throat, myalgia
- Attacks spinal ganglia, cranial nerves, and motor nuclei
What are the three different diseases associated with Poliomyelitis? (PBP)
- Paralytic disease: Various degrees of flaccid paralysis of the muscles of the legs, abdomen, back, intercostals, diaphragm, pectoral girdle, and bladder. Temporary but can have long-lasting effects
- Bulbar poliomyelitis: brain stem, medulla, cranial nerves. Loss of control of cardiorespiratory regulatory centers
- Post-polio syndrome: progressive muscle deterioration in 25% to 50% of patients decades after the initial infection
Poliomyelitis is neurotrophic, meaning it can infiltrates the ______ neurons of the ____________
motor
anterior horn of the spinal cord
Polio viurs causes what, and what information is relevant?

- RNA single-stranded virus
- Humans are the only reservoir
- Vaccination as early in life w/ four doses, starting at 2 months of age
- poliovirus (part of picornavirus family)
Mode of Transmission: fecal-oral, vehicle
Virulence: attachment mechanisms
Culture/Diagnosis: viral culture, serology
Prevention: live attenuated vaccine (developing world) and inactivated oral vaccine (developed)
Treatment: none, palliative, supportive
Epidemiological: Polio has been 99% eradicated, except in Afghanistan and Pakistan, as of 2021
Which type of paralysis does botulism and tetanus respectively cause? They are both endo/exo toxin?

Clostridium tetani is what type of microbe? (ST)

Gram+
Endospore Forming (under anaerobic conditions only)
Rod
Neonatal tetanus kills approximately ________ and the majority of infections are a direct result of ___________
35,000
unhygienic practices during childbirth
What is the biggest virulence factor for tetanus?
- Tetanospasmin
- It's a neurotoxin which binds to target sites on peripheral motor neurons on the spinal cord, brain, and sympathetic nervous system
- Blocks inhibition of muscle contraction, causing muscles to contract uncontrollably (allowing for excitatory to continue) resulting in spastic paralysis
- Death results from paralysis of respiratory muscles and respiratory arrest
Clostridium tetani causes what, and what information is relevant?
- Tetanus
- common resident of soil and GI tracts of animals
Mode of Transmission: Parenteral, direct contact
Virulence: tetanospasmin exotoxin
Culture/Diagnosis: sympotamtic
Prevention: Vaccination with tetanus toxoid (modified) in combination with diptheria and pertussis toxoid
- booster - every 10 years
- never be given to injured, non-immunized people, not completed the series, last booster was more than 10 years ago
- can also be given with passive TIG
Treatment: Combination of passive antitoxin and tetanus, toxoid active immunization, metronidazole and muscle relaxants, sedation
Epidemiological: Worldwide, +/-25,000 newborn deaths annually in developing countries
What are the basic characteristics of botulism?
- Associated with eating poorly preserved foods
- Three types: foodborne, infant, and wound (anerobic microbe
What is the major virulence factor in botulism?

- Botulinum exotoxin
- Toxin travels from the bloodstream to the neuromuscular junctions of skeletal muscles
- Prevents the release of acetylcholine, resulting in flaccid paralysis
- Botox is utilized by doctors to treat uncontrolled muscle spasms, migraine headaches, and other conditions (cosmetically as well)
Clostridium botulinum causes what, and what information is relevant?
- Botulism - gram + endospore forming
- Normally, acetylcholine (ACh) is released at the synapse to trigger muscle contraction and continue the action potential. However, in the presence of botulinum toxin, the release of ACh is blocked, preventing muscle contraction and leading to paralysis.
Mode of Transmission: Vehicle (foodborne toxin, airborne organism), direct contact (wound), and parenteral (injection)
Virulence: botulinum exotoxin
Culture/Diagnosis: culture of organism; demonstration of toxin
Prevention: Food hygiene; toxoid immunization available for laboratory professional
Treatment: Antitoxin, penicillin G for wound botulism, and supportive care
Epidemiological: United States: 75% of botulism is infant botulism; over 150 cases annually
Category A Bioterrorism Agent
Epidemiological Features
United States: 75% of botulism is infant botulism; over 150 cases annually
Category A Bioterrorism Agent
Trypanosoma brucei causes what, and what information is relevant?
- African Sleeping Sickness
- Hemoflagellate: lives in the blood and tissues of the human host
- Millions in African affected
- Transmitted by tseste fly
- Intermittent fever, enlarged spleen and swollen lymph nodes, joint pain, personality/behavioral changes, extreme fatigue and sleep disturbances (due to circadian rhythm disruptions) , uncontrollable sleepiness during the day (sleeplessness at night)
- Muscle tremors, shuffling gait, slurred speech, seizures, local paralysis
- Death results from coma, secondary infections, and heart damage
Mode of Transmission: Vector, vertical
Virulence: Immune evasion by antigen shifting
- In African sleeping sickness (caused by Trypanosoma brucei), the parasite uses antigenic variation (or antigen shifting) to evade the immune system. Here’s how it works: the parasite’s surface is covered with proteins called variant surface glycoproteins (VSGs). The immune system recognizes these proteins and makes antibodies against them. But before the immune system can eliminate all of the parasites, some of them switch to a different VSG, changing their “appearance.” This constant switching confuses the immune system and allows the parasite to stay in the host for long periods, causing a chronic infection.
Culture/Diagnosis: microscopic examination of blood, CSF
Prevention: vector control
Treatment: Suramin or pentamidine (early), eflornithine or melarsoprol (late)
Epidemiological: brucei gambiense: 7,000 to 10,000 cases reported annually; actual occurrence estimated at 600,000; T. brucei rhodesiense: estimated 30,000 cases occur annually
For the nervous system, what are the two gram + endospore forming bacteria?
Clostridium tetani
Clostridium botulinum
For the nervous system, what are the three gram + bacteria?
Streptococcus pneumonia (meningitis)
Listeria monocytogenes (meningitis, neonatal meningitis)
Streptococcus agalactiae (neonatal meningitis)
For the nervous system, what are the four gram - bacteria?
- Neiserria meningitdis (meningococcal meningitis)
- Haemophilus influenzae (meningitis)
- Escherichia coli (KI strain) - neonatal meningitis
- Cronobacter sakazakii (neonatal and infant meningitis)
What are the two DNA viruses for the nervous system?
HSV 1/2 (encephalitis)
JC virus (progressive multifocal leukoencephalopathy)
What are the RNA viruses for the nervous system?
Arboviruses (encephalitis)
Zika virus
Poliovirus
Measles virus (SSPE)
Rabies virus
What are the fungi in the nervous system?
Cryptococcus neoformans
Coccidoides
(Meningitis)
What are the prions?
Creutzfeldt-Jacob prion (CJD)
What are the protozoa (4) in the nervous system?
Naegleria fowleri (meningoencephalitis)
Acanthamoeba (meningoencephalitis)
Toxoplasma gondii (subacute encephalitis)
Trypanosoma brucei (ASS)
Chapter 22
Infectious Diseases Manifesting in the Respiratory System
Where does the lower respiratory tract begin?
Trachea, then into the bronchi, bronchioles, and alveoli
What are the anatomical defenses of the respiratory tract?
- Nasal hairs
- Ciliated epithelium (trachea and bronchi in the ciliary escalatory)
- Mucus
- Coughing, Sneezing, Swallowing
What are the additional defenses of the respiratory system?
- Complement action in lungs
- Increased cytokines and antimicrobial peptides
-
- In the alveoli of the lungs, macrophages (called alveolar macrophages) patrol the air sacs and remove any dust, debris, or microorganisms that enter when you breathe.
- In the tonsils, which are clusters of lymphoid tissue at the back of the throat, macrophages help detect and destroy pathogens that enter through the mouth or nose.Macrophages INHIBIT alveoli of lungs and clusters of lymphoid tissue in tonsils. This means that macrophages, which are immune cells that “eat” and destroy pathogens, are found in specific parts of the body where infections are likely to start.
- Secretory igA (inside mucus)
What is the normal microbiota in the respiratory tract?
- large number of commensal organisms (one species gains benefits) due to constant contact with environment
- Upper and lower respiratory tract
- Nine major bacterial genera and yeasts (especially in URT)
- Microbial antagonism
- Normal biota bacteria which can causes disease:
- Streptococcus pyogenes
- Haemophilus influenzae
- Streptococcus pneumoniae
- Neisseria meningitidis
- Staphylococcus aureus
Infectious Disease of the Upper Respiratory Tract
- Identify which disease is often caused by a mixture of microorganisms.
- Identify two bacteria that can cause dangerous pharyngitis cases.
Over 200 different types of viruses causes what, and what information is relevant?
- Common Cold (rhinoviruses, coronaviruses, adenoviruses, RSV)
Mode of Transmission: droplets and indirect
Virulence: attachment proteins, most symptoms induced by host response
- uses attachment proteins on its surface to bind tightly to receptors on the cells lining your nose and throat — this is how it successfully enters and infects those cells. Most of the symptoms you feel (like congestion, sore throat, and runny nose) aren’t directly caused by the virus destroying cells, but rather by your immune system’s response to the infection — the inflammation and release of immune molecules cause the familiar cold symptoms.
Culture Diagnosis: Not needed
Prevention: No vaccine (HYGIENE)
Treatment: ONLY supportive care no chemotherapeutic agents
Epidemiology: highest incidence among preschool and elementary schoolchildren, with average of three to eight colds per year; adults and adolescents: two to four colds per year
What are the basic characteristics to a sinusitis?
- inflammatory condition of any of the four sinuses in skull
- allergy OR infection
- Patients suffering from cold can also get this (sequela because you get fluid and mucus trapped inside sinuses, allowing bacteria and fungi to incubate)
- Sinus pain, nasal congestion, pressure, headache, toothache
- discharge is OPAQUE and can yellow and green
- Multiple causative agents: viruses (most common - same ones as cold), bacteria (from normal biota, 2% of cases), fungi (rare but occurs when antibacterial drugs can't solve)
Viruses causes what, and what information is relevant?
- Sinusitis
Mode of Transmission: direct and indirect contact
Culture Diagnosis: culture not performed, diagnoses based on clinical presentation
Prevention: hygiene
Treatment: none
Distinctive features: viral and bacteria more common
Epidemiology: follows common cold
Various bacteria (mixed infection) causes what, and what information is relevant?
- Sinusitis
Mode of Transmission: Endogenous (opportunism)
Culture Diagnosis: culture not performed, diagnoses based on clinical presentation; occasionally X-rays or imaging used
Prevention: N/A
Treatment: no antibiotic unless unresolved for some weeks
Distinctive Features: viral and bacterial more common than fungal
Epidemiology: United States: affects 1 of 7 adults; between 12 and 30 million diagnoses per year
Various fungi causes what, and what information is relevant?
- Sinusitis
Mode of Transmission: introduction by trauma or opportunistic growth
Culture Diagnosis: culture not performed, diagnoses based on clinical presentation; occasionally X-rays or imaging used
Prevention: N/A
Treatment: Physical removal of fungus, or anti-fungals in severe cases
Epidemiology: fungal sinusitis varies with geography; in the United States: more common in SE and SW; internationally: more common in India, North Africa, Middle East
What are common characteristics to acute otitis media?

- sequela to common cold
- NOT communicable disease
- many different causative agents: bacteria, viruses, yeast
- inflammation of eustachian tubes and buildup of fluid in the middle ear
- Bacteria can migrate along the eustachian tubes, increasing the inflammatory response
- Fullness/pain in ear, loss of hearing
- Young children: irritability, trouble sleeping/eating/hearing
- Infection can cause eardrum to burst
What generally causes chronic otitis media?
Fluids builds up in eustachian tubes
- caused by a mixed biofilm of bacteria attached to the membrane of the inner ear
What is the secreted fluid called?
Effusion
Streptococcus pneumoniae causes what, and what information is relevant?
- Otitis media
- most common cause
- Gram + diplococci joined end to end
Mode of Transmission: endogenous *may follow upper respiratory tract infection by S. pneumoniae)
Virulence: Capsule OR hemolysin
- Capsule – Some bacteria like Streptococcus pneumoniae have a polysaccharide capsule that helps them avoid phagocytosis by immune cells, allowing them to survive and multiply in the middle ear.
- Hemolysin – Certain bacteria (like S. pneumoniae or S. pyogenes) produce hemolysins, which are toxins that damage host cells, including those in the ear tissues. This triggers inflammation and fluid buildup, leading to ear pain and pressure.
Culture/Diagnosis: clinical symptoms and failure to resolve in 72 hours
Prevention: Pneumococcal conjugate vaccine (PCV13)
Treatment:
- Most often, “watchful waiting” for 72 hr
- Tubes can help alleviate symptoms in recurrent infections
- Amoxicillin (high rates of resistance) or amoxicillin + clauvanate + cefuroxime; antibiotic usage recommend for babies < 6 months old.
Epidemiological: 30% of cases in the U.S
Candida auris causes what, and what information is relevant?
- Yeast (Fungal)
- Otitis Media
Mode of Transmission: not KNOWN
Virulence: biofilm formation
Culture/Diagnosis: MALDI-TOF or PCR; CDC will identify if requested
Prevention: None
Treatment: Consult w/ CDC (antibiotic resistance)
Epidemiological: First appeared in 2009; increasing in U.S.
What are the common characteristics of pharyngitis? (compare viral and bacteria)
- Inflammation of throat, causing swelling and pain
- Inflammatory white packets (exudates) on walls of throats, difficulty swallowing, foul breath
- Viral - mild and sometimes lead to horseness
- Bacteria - more painful, often has fever, headache, and nausea
- Caused by the same viruses causing the common cold, but most serious cases are caused by Streptococcus pyogenes and Fusobacterium necrophorum
What are the three causative agents of pharyngitis? (SFV, not SFG)
- Streptococcus pyogenes
- Fusobacterium necrophorum
- Viruses (same ones that cause common cold)
What is a major causative agent of pharyngitis?
Streptococcus pyogenes
- Gram +
- Grows in chains
- Facultative anaerobe
- Produces capsule and slime layer
- Untreated streptococcal infections can lead to Rheumatic fever, scarlet fever, and glomerulonephritis
Virulence
- Surface antigens of S. pyogenes mimic host proteins and protect microbe from being affected by lysozyme
- M protein aid - resisting phagocytosis and adhesion
- Streptolysin O and streptolysin S: injure cells and tissues
- Erythrogenic toxin: produced by lysogenic strains of S. pyogenes, key for scarlet fever
- Some streptococcal toxins act as superantigens
Streptococcus pyogenes causes what, and what information is relevant?
- Pharyngitis
Mode of Transmission: Droplet or Direct
Virulence:
- LTA, M protein, hyaluronic acid capsule, SLS and SLO, superantigens, induction of autoimmunity
Culture/Diagnosis: beta-hemolytic on blood agar, sensitive to bacitracin
Prevention: hygiene
Treatment: penicillin, cephalexin (allergic to penicillin)
Distinctive Features: more severe than viral
Epidemological: United States: 10% to 20% of all cases of pharyngitis
Fusobacterium necrophorum causes what, and what information is relevant?
- Pharyngitis
- Gram - bacteria
- potientally dangerous bacteria that causes 15% of acute pharyngitis (>15 y/o)
- Causes peritonsillar abscess called Lemierre's syndrome (life threatening, mostly in males and sepsis via drainage which can be sent to jugular vein and the heart)
Mode of Transmission: endogenous
Virulence: Invasiveness, endotoxin
Culture/Diagnosis: Culture anerobically, CT for abscess
Treatment: Penicillin
Distinctive: can lead to Lemierre's syndrome
Epidemiological:
Causes up to 15% of acute pharyngitis in teens/young adults
Viruses causes what, and what information is relevant?
- Pharyngitis
Mode of Transmission: all forms of contact
Culture/Diagnosis: Goal is to rule out S. pyogenes (and F. necrophorum); further diagnosis usually not performed
Prevention: Hygiene
Treatment: Symptom relief
Distinctive: hoarseness
Epidemological: ubiquitous; responsible for 40% to 60% of all pharyngitis
Diseases in Both Upper and Lower Respiratory Tracts
ONLY 3 - Whooping Cough, RSV, and Influenza
What is the basic information regarding whooping cough, and what are the three stages? (CPC)
- Pertussis
- Catarrhal Phase: bacteria in respiratory tract cause cold symptoms
- Paroxysmal Phase: most contagious, almost last 6 wees, coughing sheds microbes into the air: UNCONTROLLABLE coughing with whooping sound, can result in broken vessels in eye, vomiting, hemorrhages in brain
- Convalescent Phase: bacteria are decreasing, but ciliated epithelia have been damaged, requiring weeks to months of recovery
T or F: Bordetella pertussis is gram + and anerobic
False;
small, gram -
STRICTLY aerobic
Bordetella pertussis causes what, and what information is relevant?
- Pertussis (Whooping Cough)
- Small, Gram -, strictly aerobic, fastidious
Mode of Transmission: DROPLET contact
Virulence:
- Filamentous hemagglutinin: essential for attachment/adhesion
- Pertussis toxin: causes massive mucus production
- Tracheal cytotoxin: causes direct destruction of ciliated cells
- Endotoxin: leads to the production of a host of cytokines (When a pathogen infects the body, it can cause an overproduction of cytokines (a “cytokine storm”). This intense immune response can lead to tissue damage, inflammation, and worsening symptoms.)
Culture/Diagnosis: PCR or growth on blood agar, charcoal, or potato-glycerol agar, diagnosis can be made on symptoms
Prevention: high vaccination coverage has kept incidence low in the U.S. Current vaccines are acellular formation of antigens. Booster needed after 11 y/o
Treatment: Azithryomycin; drug resistant B. pertussis is concerning threat
Epidemiological: United States: 19,000 cases in 2017, 14,000 in 2018; internationally: hundreds of millions of cases annually
What are the basic characteristics for RSV?
- Respiratory Syncytial Virus
- Infects the respiratory tract and produces giant multinucleated cells (syncytia)
- peak incidence in winter and early spring
- Premature babies as well as children 6 months of age or younger are especially susceptible
- Signs/Symptoms: fever (3 days), rhinitis, pharyngitis, otitis
- More serious infection - progress to bronchial tree, parenchyma, croup and difficulty breathing, w/ stridor
- Highly contagious through droplet and fomites
- Passive antibody therapy and ribavirin is available through inhaled aersol
Respiratory syncytial virus causes what, and what information is relevant?
- RSV
Mode of Transmission: droplet and indirect
Virulence: syncytia formation
Culture/Diagnosis: RT-PCR
Prevention: Passive-antibody (humanized monoclonal) in high-risk children
Treatment: ribavirin plus passive antibody for severe cases
Epidemiological: United States: general population, less than 1% mortality rates, 3% to 5% mortality in premature infants or those with congenital heart defects; internationally: seven times higher fatality rate in children in developing countries
What are the basic characteristics for Influenza
- All cases of influenza are caused by one of three influenza viruses: A, B, or C, belonging to the Orthomyxoviridae family
- Headache, chills, dry cough, body aches, fever, stuffy nose, and sore throat, extreme fatigue (few days to weeks)
- Leave patients to secondary infections, leading to pneumonia
- Patients with emphysema or cardiopulmonary disease, along with very young, elderly, or pregnant patients, are more susceptible to serious complications
What are the influenza glycoproteins?

Hemagglutinin (H):
- Has agglutinating action on red blood cells
- Binds to host cell receptors of respiratory mucosa
Neuraminidase (N):
- Breaks down protective mucus coating of the respiratory tract
- Assists in viral budding and release
- Participates in host cell fusion
What is the difference between antigenic drift and antigenic shift?
We get flu shots every year because the glycoproteins (hemagglutinin and neuraminidase) on the influenza virus mutate frequently — a process called antigenic drift.
- Antigenic drift: gradual changing of amino acid composition of influenza antigens which results in decreased ability of host memory cells to recognize them
- Antigenic shift: swapping out of one of the strands of viral RNA with a gene or a strand from a different influenza virus (infected host has both subtypes), and there is NO recognition by host memory cells
The _______ air of __________ facilitates the spread of the virus as it helps the virus remains airborne for more extended periods of time
drier
winter
- Cold air makes respiratory tract mucous membranes more brittle, facilitating invasion by viruses
- Mucous membranes are less viscous, which enables the flu-virus to penetrate the cells and the epithelium very easily
Influenza A, B, and C viruses causes what, and what information is relevant?
- Influenza
Mode of Transmission: Droplet, direct, and indirect
Virulence: Glycoprotein spikes, antigenic shift and drift
Culture/Diagnosis: RT-PCR
Prevention: vaccines
- Three major types of influenza vaccines in the United States:
- Inactivated, Recombinant, and Live Attenuated influenza vaccines
- The vaccine does not cause the flu
Treatment: Oseltamivir (Tamiflu), baloxavir (Xofluza)
Epidemiological: For seasonal flu, deaths vary from year to year; United States: range from 17,000 to 52,000; internationally: range from 250,000 to 500,000
What are the four infectious diseases only in the lower respiratory system?
1. Tuberculosis
2. Community-acquired pneumonia (3 causes)
3. Hospital-acquired pneumonia
4. Hantavirus pulmonary syndrome
What are the basic characteristics about Tuberculosis?
- Ancient disease, now remerging due to HIV epidemic, drug-resistant strains, and 1/3 of the world is infected
- Main cause is bacteria Mycobacterium tuberculosis
What are the different types of tuberculosis?

1. Primary
- Infectious dose: 10 bacteria
- Bacteria continue to multiply inside alveolar macrophages
- Tubercles: Granulomas containing a core of TB bacteria in enlarged macrophages and an outer wall made of fibroblasts, lymphocytes, and macrophages
- Can become necrotic caseous lesions which can be calcified
- Breakdown of these calcified lesions can lead to secondary or reactivation of TB
2. Extrapulmonary TB
- Organs involved: regional lymph nodes, intestines, kidneys, long bones, genital tract, brain, meninges
3. Secondary (reactivation) TB
- Dormant bacteria in the lungs can be reactivated when immunity wanes
- Able to remain dormant for weeks, months, or years later
- Severe symptoms: violent coughing, greenish or bloody sputum, low-grade fever, anorexia, weight loss, fatigue, night sweats, and chest pain
- Actually get the disease - the untreated disease has a 60% mortality rate
What are the different testing methods for TB? (5)

1. The TB skin test (Mantoux test)
- causes a welt (raised bump) if you’ve been exposed to Mycobacterium tuberculosis because of a delayed-type hypersensitivity reaction — an immune system response mediated by T cells, not antibodies.
- Tuberculin reaction
Here’s what happens:
- The test injects a small amount of tuberculin (purified protein derivative, PPD) just under the skin.
- If you’ve been exposed to TB before, your memory T cells recognize the TB proteins in the PPD.
- Those T cells release cytokines, which recruit macrophages and other immune cells to the site.
- This causes localized inflammation, resulting in a firm, raised welt within 48–72 hours.
So the welt doesn’t mean you currently have active TB — it just means your immune system has seen TB antigens before (from infection or vaccination).
2. IGRA: blood test to determine T-cell reactivity to M. tuberculosis
IGRA stands for Interferon-Gamma Release Assay — it’s a blood test used to detect Mycobacterium tuberculosis infection (like the TB skin test, but more specific).
Here’s how it works
Mycobacterium tuberculosis causes what, and what information is relevant?
- Long, thin, acid-fast rod, strict aerobe
- Lipid component in mycobacterial cell wall associated with viral strains (mycolic acid and waxes makes organisms resistant to drying and disinfectants)
- MAC (mycobacterium avium Complex, causes disseminated tuberculosis infection in AIDs patients)
Mode of Transmission: Vehicle (airborne)
Virulence: Lipids in wall, ability to stimulate strong cell-mediated immunity (CMI)
Culture/Diagnosis:
Culture, PCR test (Xpert®), IGRA, complemented by skin test and chest X-ray
Prevention: Avoiding airborne M. tuberculosis AND BCG vaccine in other countries
Treatment:
- Active tuberculosis: First 2 months: Rifampin, isoniazid, ethambutol, pyrazinamide
- Four to seven months: uses only two drugs that susceptibility testing have shown to be effective
- Patient noncompliance leads to drug-resistant strains: Multidrug-Resistant Tuberculosis (MDR-TB)
- Extensively Drug-Resistant Tuberculosis (XDR-TB)
Distinctive Features: Remains airborne for long periods; extremely slow-growing, which has implications for diagnosis and treatment
Epidemiological: remains airborne for long periods; extremely slow-growing, which has implications for diagnosis and treatment
MDR-TB and EDR-TB causes what, and what information is relevant?
- TB
Mode of Transmission: Vehicle (airborne)
Virulence: lipids in wall, ability to stimulate strong cell-mediated immunity (CMI)
Culture/Diagnosis: culture, PCR test (Xpert®), IGRA, complemented by skin test and chest X-ray
Prevention: avoiding airborne M. tuberculosis; BCG vaccine in other countries
Treatment: multiple-drug regimen, which may include pretomanid, bedaquiline; and linezolid; in Serious Threat category in CDC Antibiotic Resistance Report
Distinctive Features: much higher fatality rate over shorter duration
Epidemiological: United States: a fewer cases per year; worldwide: 500,000 new infections with MDR-TB in 2020
What is the basic characteristics of pneumonia?
- Inflammatory condition of the lung in which fluid fills the alveoli
- Caused by many microbes which must be able to AVOID phagocytosis or AVOID being killed once inside alveolar macrophages
- Viral is generally milder than bacterial
- Begins with runny nose, congestion, headache, fever
- Lung: chest pain, fever, cough, discolored sputum
- Pale and sickly due to pain and difficulty breathing
What are the 6 different causative agents for CAP, separated based on mode of transmission?
RSM HPL
1. Droplet
- Rhinoviruses (or endogenous transfer)
- Streptococcus pneumoniae (or endogenous transfer)
- Mycoplasma pneumoniae
2. Vehicle (Inhalation of Spores)
- Histoplasma capsulatum (in soil)
- Pneumocystis jirovecii
3. Vehicle (Water Droplets)
- Legionella species
Rhinoviruses causes what, and what information is relevant?
Mode of Transmission: Droplet contact (or endogenous transfer)
Virulence: N/A
Culture/Diagnosis: Failure to find bacteria or fungi
Prevention: Hygiene
Treatment: None
Distinctive Features: Mild
Epidemiological: 9% of CAP cases
Streptococcus pneumonia causes what, and what information is relevant?

- CAP
- Small, gram + flattened coccus in pairs
- Alpha-hemolytic
- For 50% of healthy people, it's in normal microbiota
- Infection occurs when bacteria is inhaled into deep areas of lungs or shared respiratory droplets between people
Mode of Transmission: Droplet contact (or endogenous transfer)
Virulence: CAPSULE
- Polysachharide component prevents effective phagocytosis, blocks complement, causes inflammatory buildup in lung
Culture/Diagnosis: Gram-stain, alpha-hemolytic on blood agar
Prevention: Vaccine (children and older adults) - PCV13 or PPSV23
Treatment: doxycycline, ceftriaxone, with or without vancomycin; much resistance
Distinctive Features: SEVERLY ILL
- Organism is resistant to penicillin and its derivatives, macrolides, tetracyclines, and fluoroquinolones
Epidemiological: 5% of cases, serious threat
Mycoplasma pneumoniae causes what, and what information is relevant?
- (CAP) Walking pneumonia/atypical pneumonia (symptoms do not resemble those of pneumococcal or other ones)
- LACKS a cell wall, irregulary shaped
- Transmitted by aersol droplets among individuals
- Diagnosis through ruling out other causes, PCR, or serological analysis
Mode of Transmission: Droplet
Virulence: Adhesins
Culture/Diagnosis: Rule out other etiologic agents; serology; PCR
Prevention: No vaccine, no permanent immunity
Treatment: erythryomycin
Distinctive Features: mild, walking pneumonia
Histoplasma capsulatum causes what, and what information is relevant?
- Darling disease
- Ohio Valley Fever, Spelunker's Disease
- Benign/Severe, Acute/Chronic
- Healthy people can fight out, but immunocompromised can lead to lesions in lungs
- Most serious forms in those with AIDS
- Chronic pulmonary histoplasmosis: signs and symptoms similar to TB
- Endemic to all continents except Australia
Mode of Transmission: Vehicle (inhalation of spores in contamined soil)
Virulence: Survival in phagocytes
Culture/Diagnosis: Rapid antigen tests, microscopy
Prevention: Avoid soil with bird and bat droppings
Treatment: Itraconazole
Distinctive Features: many asymptomatic infections
Epidemiological: the United States, 250,000 infected per year; 5% to 10% have symptoms
Pneumocystitis jirovecii causes what, and what information is relevant?
- CAP
- Agent of pneumocystits pneumonia (PCP pneumonia)
- Primarily in those w/ AIDS
- normal biota in healthy people
- Fungus multiplies intracellularly and extracellularly
- Antifungals are ineffective, can have lesions all over heart, lungs, skin, liver, if you don't have a properly functioning immune system
Mode of Transmission: Vehicle (inhalation of spores)
Virulence: N/A
Culture/Diagnosis: Microscopy
Prevention: Antibiotics given to AIDS patients
Treatment: Trimethoprim/sulfamethoxazole
Distinctive Features: mostly occurs in AIDS patients
Epidemiological: exclusively in severely immunocompromised patients
Legionella pneumophila causes what, and what information is relevant?
- CAP Pneumonia
- Weakly gram negative (various shapes)
- Legion convention outbreak
- Widely distributed in aqeous environments (tap water, cooling towers, spas, ponds, and freshvirus)
- Opportunistic disease (mostly in elderly, rarely in healthy children and adults)
Mode of Transmission: Vehicle (water droplets)
Virulence: N/A
Culture/Diagnosis: Urine antigen test, culture requres selective charcoal yeast extract agar
Prevention: N/A
Treatment: Fluoroquinolone, azithromycin, clarithromycin
Distinctive Features: Mild pneumonias in healthy people; can be severe in elderly or immunocompromised
Epidemiological: United States: on the rise; 6,000 to 8,000 cases annually
Gram-negative and gram-positive bacteria from upper respiratory tract or stomach; environmental contamination of ventilator
causes what, and what information is relevant?
- Healthcare-Associated Pneumonia
- Most causes are due to ASPIRATION from UPT
- Elevation of patients’ heads to 30 to 45° angle helps reduce aspiration of secretions as well as proper care of ventilation and respiratory equipment
- Deep breathing; frequent coughing
- Empiric antibiotic therapy started asap
- 1% of hospitalized people develop, often associated with mechanical ventilation via endotracheal or tracheostomy tube
- 30-50% mortality rate
- Staphylococcus aureus (usually MRSA)
- Klebsiella pneumoniae
- Enterobacter
- Escherichia coli
- Pseudomonas aeruginosa
- Acinetobacter
- Most cases are polymicrobial in origin
Mode of Transmission: Endogenous (aspiration)
Virulence: N/A
Culture/Diagnosis: culture of lung fluids
Prevention: Elevating patient’s head, preoperative education, care of respiratory equipment
Treatment: Varies by etiology
Epidemiological: United States: 300,000 cases per year; occurs in 0.5% to 1.0% of admitted patients; mortality rate in the United States and internationally is 20% to 50%
What are the basic characteristics for Hantavirus?
- Symptoms during prodromal phase: fever, chills, myalgias, hedache, n, v, d
- Cough is common, but not early symptom
- Soon, severe pulmonary edema and acute respiratory distress occur
- Severe breathing difficulties after hantavirus antigen spreads through blood
Hantavirus causes what, and what information is relevant?

** virulence factor here is not the virus itself, but it causes overactivation of the immune system leading to respiratory distress and inflammatory response
Transmission and epidemiology:
- Airborne via dust contaminated with urine, feces, or saliva of infected rodents
- Incidence is increasing in areas of the United States, west of the Mississippi River
Treatment and prevention:
- Diagnosis through detection of IgM antibody to hantavirus or PCR techniques
- Supportive Care